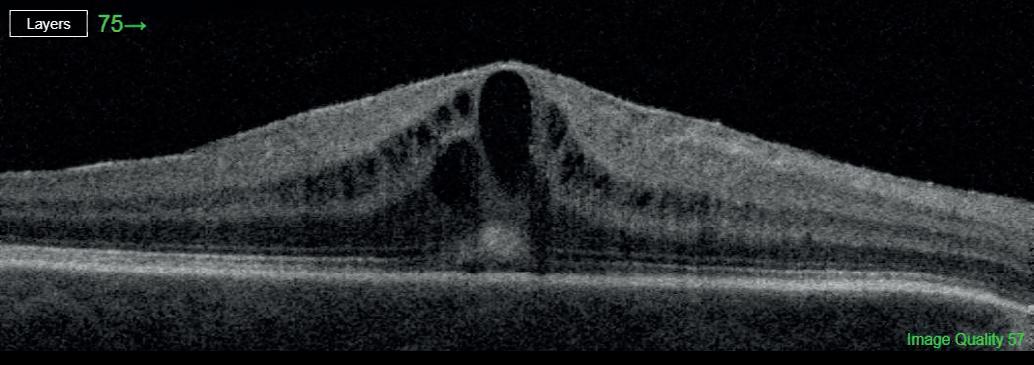
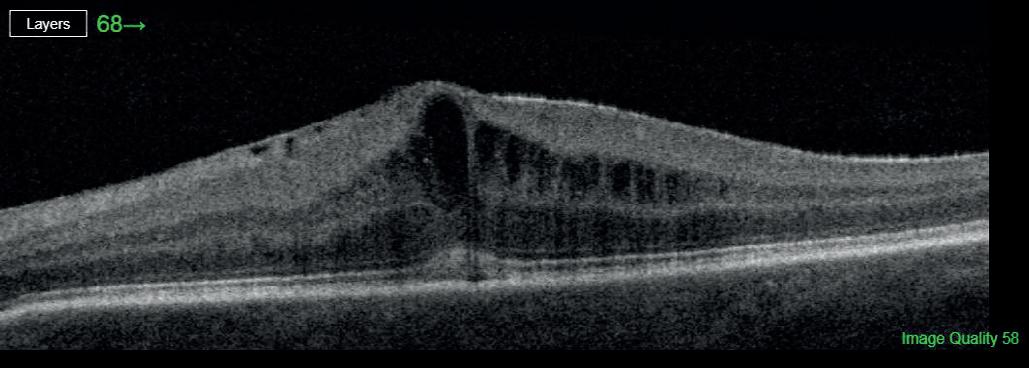
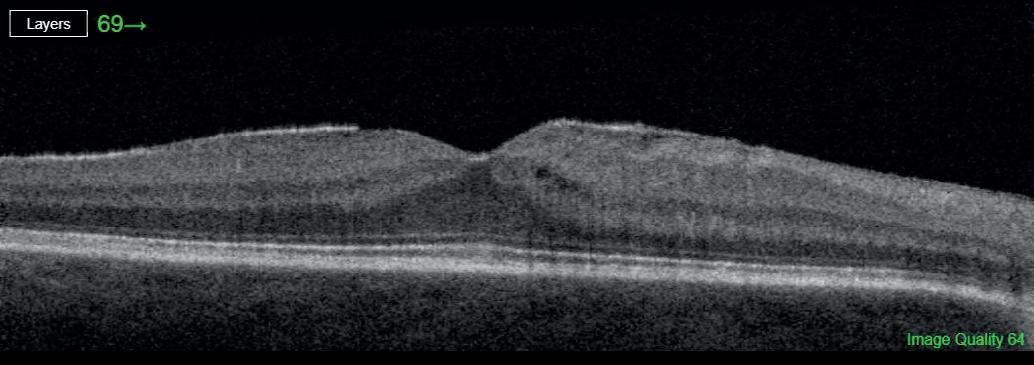

LIFTING





SCREEN TIME Digital eye strain and the toll it takes on children


















CORNEA A look at one of the most extraordinary parts of the eye



GENETIC NURTURE Do virtual parents pass down myopia to our children?



CPD CPD
ISSN 2632-0584 Winter 2023 college-optometrists.org
How can optometrists help relieve patients of their treatment burden?
PLAY YOUR PART How to speak up and change the future of optometry PROFESSIONAL EXCELLENCE IN EYE HEALTH
THE LOAD
The Young Eye: Assessment of Vision
Examining children often requires an adapted approach to both communication style and the tests used. In this three-part course, two experts come face to face with children aged a few months to 18 years and show how adjusting the consultation can turn the typical challenges of assessing children’s vision into a rewarding process for the practitioner.
The course also includes an updated version of the Docet Examining Children Booklet and a comprehensive Glossary of Tests used when examining younger patients.
To take this course and discover more CPD visit www.docet.info

Search docet.info
Managed and delivered by The College of Optometrists and funded by the UK’s Health Departments,
OPINION
11

Clear view
The College’s Clinical Editor, Jane Veys MCOptom, on the value of curiosity in the clinical world 12 Big


question
What can be done to minimise treatment burden for patients? 16 One to one

Evelyn Mensah, Consultant Ophthalmologist, on what she is doing to encourage equality
PRACTICE
18 Screen time
How is children’s increased use of digital devices impacting their eye health? 23 Refresher

Explore the wonders of the cornea and promising research avenues in corneal innervation 26 Clinical notes The scope of practice and eye care services in optometry 28 Ageing
Supporting older patients whose quality of life has been affected by eye disease
Case study Complications arising from postoperative cataract surgery, leading to reduced visual outcomes

AMD How does the causal relationship between agerelated macular degeneration and atrophy of the visual cortex work?

Genetics Does genetic nurture play a significant role in the childhood development of myopia alongside genetics?

Career profile A conversation with Denise Voon MCOptom on her award-winning work at Amersham Hospital
BUSINESS
How to... Speak up and shape the future of the profession
Health coaching How can health coaching strengthen the patientpractitioner relationship? 50 Did you know..? The optical landscape in numbers
THE COLLEGE OF OPTOMETRISTS 42 Craven Street London WC2N 5NG 020 7839 6000 college-optometrists.org EDITORIAL BOARD Iftab Akram MCOptom Farah Awan MCOptom Dr Tamsin Callaghan MCOptom Dr Sandeep Dhallu MCOptom Dr Neema Ghorbani MCOptom Rashida Makda MCOptom Dr Annette Parkinson MCOptom Farhana Patel MCOptom Preeti Singla MCOptom Jane Veys MCOptom EDITORIAL LEAD Isabelle Rameau EDITOR Emma Godfrey emma@acuityjournal.co.uk CONTENT SUB-EDITORS James Hundleby, Amy Beveridge DESIGNER Tom Shone PICTURE EDITOR Akin Falope ADVERTISING 020 7324 2735 advertising@acuityjournal.co.uk PRODUCTION Rachel Young 020 7880 6209 rachel.young@redactive.co.uk PUBLISHING DIRECTOR Aaron Nicholls PRINTER Warners Midlands COVER Getty Full references can be found at college-optometrists.org/acuity © The College of Optometrists 2023 All views expressed in Acuity are not necessarily those of the College of Optometrists. All efforts have been taken to ensure the accuracy of the information published in Acuity. However, the publisher accepts no responsibility for any inaccuracies or errors and omissions in the information produced in this publication. No information contained in this publication may be used or reproduced without the prior permission of the College of Optometrists. Recycle your magazine’s plastic wrap. Check your local LDPE facilities to find out how. TO READ THIS ISSUE’S FEATURES ONLINE, AND TO CATCH UP WITH ALL PREVIOUSLY PUBLISHED ARTICLES, VISIT COLLEGE-OPTOMETRISTS.ORG/ACUITY 5 Editorial College President Professor Leon Davies FCOptom NEWS 7 News in numbers The clinical figures that count 8 News analysis Stories behind the headlines 10 Tech news New advances in technology 32
35
38
42
44
47
3 WINTER 2023 Acuity WINTER 2023
36 12 35 47 44 18
CONTENTS THE JOURNAL OFTHE COLLEGE OF OPTOMETRISTS
Optometry Tomorrow
Bitesize will take place online between 23 and 28 April 2023.

You can look forward to a week of sessions including webinars and online peer reviews. Up to six interactive CPD points can be earnt.
Look out for College communications for further details.
Show your patients that you are a member of your professional body and committed to their care, by displaying a College member sticker in your practice window.
You can order your new College window sticker online here: college-optometrists.org/membership/member-resources

Save the date! 2023
window stickers
College
elcome to the first issue of Acuity of 2023. I hope you were able to take time away from work to rest and reflect, and that you are now ready to seize the opportunities that a new year affords.


Over the past three months, I have continued to work hard as President to raise the profile of optometrists and to reinforce the College’s position as the voice of optometry across the UK.
During this time, a particular highlight for me was the College’s Diploma Ceremony – our first since 2019 – at Central Hall Westminster, London, where I was able to welcome more than 600 new optometrists to our profession. Two ceremonies ensured that the achievements of our newest members and higher qualification recipients, all of whom overcame the challenges of the pandemic, could be recognised.
I was also delighted to celebrate the outstanding achievements of five new Life Fellows and three Honorary Fellows of the College, along with colleagues whose research endeavours in the fields of optometry, optics and vision science were acknowledged by the College’s prestigious Research Excellence Awards. With such an abundance and diversity of talent on show, I was reminded that the future of our profession remains bright.
In terms of current and future practice, one area of our clinical work that is becoming ever more important is the identification and management of myopia. While there has been a long debate concerning the precise role of genetics and environmental factors in the development
PROFESSOR LEON DAVIES


CELEBRATING SUCCESS
concept in the light of recent evidence.
While I am keen not to dwell on the pandemic, those readers with young families will know from first-hand experience that the series of lockdowns led to a significant and sustained increase in screen time among children and adolescents. Our article on page 18 shares the thoughts of leading clinical academics on the impact of these behavioural shifts in terms of increasing symptoms associated with digital eye strain, dry eye disease and advancing myopia.
of refractive error, recent research has focused on the putative impact of “genetic nurture”, which describes the genetic effects transmitted indirectly from parents and other relatives to a child. Our article on page 38 gathers opinions from leading UK myopia researchers who discuss this
With a range of other topics covered in this quarter’s issue of Acuity, all that remains for me to do is to wish you all a happy and productive 2023.

Leon Davies FCOptom, President leon.davies@college-optometrists.org

With such talent on show, I was reminded that the future of our profession is bright
ILLUSTRATION: SAM KERR
5 EDITORIAL Acuity WINTER 2023
W

you
your
Acuity?
Have
come across interesting or challenging cases in
practice that you would like to share with readers of
Your case study should be approximately 1,000 words long, and illustrated with high-quality images. We will provide you with guidance on how to structure the case study, and a release form for your patient to sign. We will pay £250 for each case study we publish. To find out more, please email acuity@college-optometrists.org
NEWS IN NUMBERS
THE CLINICAL FIGURES THAT COUNT
A
WHO target to achieve a

A $10.3m grant has been given to the University of Rhode Island to develop retinal imaging to screen for early changes associated with Alzheimer’s disease.
(University of Rhode Island, 2022)
S40%
Topical antibiotics used to treat conjunctivitis in children significantly reduced the proportion with symptoms on days 3 to 6, compared with those receiving a placebo.
(Honkila et al, 2022)
increase in effective refractive error coverage by 2030 will require “substantial improvements in quantity and quality of refractive services” if it is to be met.
(Bourne et al, 2022)
In a study of 508 patients, higher intraocular pressure variability was associated with greater changes in RNFL thickness in glaucoma patients.
(Nishida et al, 2022)
A study involving 65,144 participants with a mean age of 56.8 found AI-enabled retinal vasculometry could help predict risk of stroke and myocardial infarction.
(Rudnicka et al, 2022)
As monkeypox cases reach 75,348 worldwide, a study says eye health professionals may play an important role in its diagnosis and management because of its associations with rare forms of severe ocular disease.
(CDC, 2022; Kaufman et al, 2022)
UK researchers have identified 5 genetic variants that may increase a person’s risk of myopia, the longer they remain in school.
(Astreinidou, 2022)
Acuity WINTER 2023 NEWS 7
BEHIND THE
NIC FLEMING LOOKS AT THE EYE HEALTH
The retinal pigment epithelium (RPE) drives the reversal of this process to restore the sensitivity of opsins to light, enabling the visual cycle to begin again. A protein called RPE65 plays a key role by binding to RPE cells.

In a paper published in the journal Life Science Alliance, a team at the US National Eye Institute highlighted how previous, crystallographybased experiments
have failed to reveal the structure of a key region of RPE65.
RPE65 drives visual cycle
Researchers have identified new details about the role of vitamin A in enabling the eye to sense light. The discovery could inform the hunt for new therapies for a number of visual impairments.
When light hits photosensitive pigments called opsins in the retina, a chemical called 11-cis retinal, derived from vitamin A, is converted into the molecule all-trans retinol. This triggers chemical reactions that generate the electrical signals that form the basis of vision in the brain.
Using biochemical and biophysical techniques, the group found the region transformed into a spiral-like shape in the presence of RPE cell membranes, enabling RPE65 to lock onto the cells and keep the visual cycle functioning. Computer modelling-based simulations supported their findings.
Improved understanding of the precise role of RPE65 in the visual cycle could help researchers develop new therapies.
It is, however, likely to be some years before these findings are translated into patient benefits. bit.ly/3Z94VRQ
CLAIM
Smaller optic cups lead to oedema in astronauts

Most astronauts experience changes to the structures of their eyes and brains while in space flight, including swelling at the back of the eye called optic disc oedema (ODE).
The size of effects and time of onset of ODE varies widely between individuals. While changes tend to be reversed when crew members return to Earth, there are concerns that extended missions, such as those being proposed to the moon and Mars, could increase the risk of permanent vision problems.
SCIENCE PHOTO LIBRARY / NASA / ISTOCK
IMAGES:
CLAIM
8 NEWS ANALYSIS Acuity WINTER 2023
HEADLINES NEWS ANALYSIS
ISSUES THAT ARE MAKING THE NEWS
US-based researchers analysed data on 31 astronauts who spent six to 12 months on the International Space Station. They found that 23 of the astronauts developed signs of ODE. Average total retinal thickness increased from a pre-flight average of 392.0μm to 430.2μm after around 150 days in space.

It has previously been suggested that those with a small or non-existent optic cup, an area at the centre of the optic disc, are more at risk of developing ODE during spaceflight (Stenger et al, 2019).
In the new study, published in JAMA Ophthalmology, the researchers found that astronauts with small, shallow and narrow optic cups pre-flight experienced larger increases in retinal thickness while in space. No other pre-flight ocular measures were associated with ODE.
Only six women took part in the study, so it is limited in its applicability to female astronauts. It was also not possible for in-flight measurements to be collected after the same number of days, and the length of time since participants had taken part in previous space missions was not considered.
The findings, nonetheless, support the idea that astronauts with smaller optic cups may benefit from increased monitoring and use of countermeasures. bit.ly/3igZr70

CLAIM
The colour of primates’ eyes is partly the result of how much light they and their species are exposed to in their natural habitats, according to new research.
A number of studies over the past 20 years have concluded that the appearance of primates’ eyes has evolved mainly as a means of communication. If correct, variations in their size and colour would be largely down to the advantages gained from how they appear to others, both within and between species, such as through signalling gaze direction or camouflage (Kobayashi et al, 2001).

Psychologist Juan Olvido PereaGarcía, of Leiden University in the Netherlands, and colleagues at the National University of Singapore recorded data on the eyes of 77 species of advanced primates from more than 1,600 photographs. They then used these to re-assess existing hypotheses about inter-species differences in eye appearance.
In a paper published in the journal Scientific Reports, they found that primates living furthest from the equator tend to have lighter conjunctiva and are more likely to have blue or green eyes.
Blue light helps tune circadian clocks and adjust energy levels. In regions with lower light levels, bluer irises may enable blue light to reach the retina and boost energy.
Perea-García and colleagues suggest natural selection has played an important role in the emergence of blue irises in northern human populations.
They conclude that ecological factors play a greater role than communication functions across the primates they studied.
They used species’ distance from equator as a proxy for light levels, but did not take into account other factors such as habitat openness, and only included two nocturnal species in their sample.
The study also tested only existing hypotheses, which leaves open the possibility of there being other, underexplored, explanations for eye colouring that they did not consider.
bit.ly/3Q8xHy5
Light exposure varies primate eye colour 9 Acuity WINTER 2023
GENE THERAPY FOR STARGARDT DISEASE IN THE OFFING
Scientists at the National Eye Institute have found the first direct evidence that Stargardt-related ABCA4 gene mutations affect the retinal pigment epithelium (RPE).
The discovery points to a new understanding of the progression of this rare inherited blinding disease and suggests a therapeutic strategy. The research team used a new stem cell-based model made from skin cells, according to the study published in Stem Cell Reports.


Their work provides direct evidence that the loss of ABCA4 function in human RPE contributes to STGD1 cellular phenotypes, in addition to its known function in photoreceptors.
Stargardt, which causes progressive loss of central and night vision, affects about one in every 10,000 people in the UK.
bit.ly/3G6OX26
COMMON CHOLESTEROL AND DIABETES DRUGS COULD LOWER RISK OF
AMD
The use of common drugs to lower cholesterol and control type 2 diabetes could reduce the risk of age-related macular degeneration (AMD) in Europeans.

A study, published in the British Journal of Ophthalmology, found the use of common drugs to lower cholesterol or control diabetes were associated with, respectively, 15% and 22% lower prevalence of any type of AMD in European populations.
3D MAP REVEALS GENETIC INSIGHTS INTO HUMAN RETINA
3D imaging of chromatin in human retinal cells has been mapped by the National Eye Institute at high resolutions. These results have been combined with other key features of the retinal cells and gene maps to produce a series of analyses that shed light on how genes are expressed generally, but also how the complex genes associated with common and rare eye diseases may act with other factors to influence disease expression.
The study, published in Nature Communications, is the first such integration of 3D mapping with mapping of genes and other key factors.
The specialised nature of adult human retinal cells, which do not divide, provided the stability needed to investigate chromatin’s 3D structure.
TECH NEWS
According to the paper, researchers found “distinct chromatin interactions at retinal genes”, suggesting their important role.

bit.ly/3GcswbY
OCT ASSESSES DRINKING AND SMOKING DAMAGE IN FOETAL BRAINS
Over $3m in funding is helping researchers to investigate the foetal brain and assess how it is impacted by maternal drinking and smoking.
In this investigation, researchers pooled the results of 14 population-based and hospital-based studies looking at 38,694 people from France, Germany, Greece, Ireland, Italy, Norway, Portugal, Russia and the UK.
AMD causes severe visual impairment among older people in high-income countries, with 67 million people in Europe alone having the condition.
bit.ly/3WFqCrp
Kirill Larin, Professor of Biomedical Engineering at the University of Houston, is developing a new imaging platform using high-resolution optical coherence tomography (OCT) to visualise dynamic changes in foetal physiology. He previously reported that prenatal ethanol exposure produces rapid and sustained decreases in bloodflow through the middle cerebral artery and pial/peri-neural vascular plexus, which supplies blood to the foetal brain. Using this new OCT platform, he will explore this discovery even further.
Larin said: “The tools will enable us – for the first time – to get dynamic, time-resolved assessment of capillary permeability and monocyte precursor invasion.”
bit.ly/3WYprCY
IMAGES: SCIENCE PHOTO LIBRARY
10 TECH NEWS Acuity WINTER 2023
A GLANCE AT WHAT’S HAPPENING IN THE WORLD OF TECHNOLOGY
JANE VEY S






Carry on being curious
to understanding each patient’s unique experience of their refractive correction and/or eye disease, and the impact on their lives.

The dictionary defines curiosity as “an eager desire to know or learn about something”. The word comes from the Latin cura meaning “to take care of”. Dissecting the etymology helps us realise that the benefits of being curious extend beyond patient outcomes, to potentially advancing our own career and finding a healthy work/life balance.
E

ver since I dissected a pig’s eye in school biology lessons, the wonders of the ocular structure have never ceased to fascinate me. “The most important square inch in the human body,” one enthusiastic lecturer claimed. My wonder and awe of this amazing organ of sight has not waned.


The wonders of the cornea in particular. How can such a complex, multilayer cellular structure be transparent? How can such a small, thin, sensitive tissue be so powerful? 43D! How amazing that a new layer or sub-layer has been discovered (and debated) within the last decade. These facts and more are covered in our article on page 23 – a great read to remind yourself of what you learned long ago, and to discover how innovative technology, such as in vivo confocal microscopy, can aid our understanding of the corneal nerve
fibre architecture in health and disease. As technology continues to advance, I am curious to know what the next ocular phenomenon will be uncovered.
Curiosity is a quality that should be valued in the clinical world. It drives learning and the exchange of ideas in an ever-changing field and leads us to ask questions, explore and collaborate. Curiosity can help us embrace new technology, and above all allow us to get to know our patients.

Understanding our patients is critical to successful clinical outcomes. Our cover feature on page 12 explores the emerging concept of treatment burden, how it can affect patients’ adherence to medication and attending ongoing appointments, and is linked to worse medical outcomes (Alsadah et al, 2022). A respectful and healthy level of curiosity is fundamental
Taking care of our own careers and helping shape the future profession can be hugely rewarding. “I got involved out of curiosity,” Farra Raqib MCOptom answered when asked why she became involved in her local optical committee. Our article on page 44 asks a number of optometrists at all stages of their career how they got involved in the profession outside of the consulting room, and the rewards they reaped as a result. So what kind of difference will you make?
As an optometrist, enjoy being curious – continue to wonder, question and reflect for the benefit of your patients and yourselves. Curiosity has led to inventions, sight- and life-saving devices, solved world problems (and boy do we need that now!) and so much more. Potentially, there is an Albert Einstein in all of us. In his own words: “I have no special talent – I am only passionately curious.”
Jane Veys MCOptom, Clinical Editor jane.veys@college-optometrists.org
ILLUSTRATION: CAROLINE ANDRIEU
Curiosity is a quality that should be valued in the clinical world
11 Acuity WINTER 2023 CLEAR VIEW
The idea that the “treatment burden” affects a patient’s adherence to medications, adaptations and attending ongoing appointments, and is linked to worse medical outcomes, is emerging in healthcare literature (Alsadah et al, 2022).
A wide range of chronic eye conditions and comorbidities with other diseases can have an impact on a patient’s quality of life. From drops and lasers for primary open angle glaucoma to intravitreal injections for eye conditions such as diabetic macular oedema, treatment burden can be relevant to a variety of medical interventions.
One study of 22 glaucoma patients found that, while there was considerable variation in how much people experienced treatment burden, “understanding glaucoma treatment burden and its influencing factors is important as we work to deliver patientcentred care and prevent vision loss” (Stagg et al, 2021).
Janki Barai MCOptom is a specialist optometrist based at a London hospital, and works as a locum in a high-street practice and with the charity Glaucoma UK. “I’ve seen treatment burden from quite a few points of view,” she says. “It is being discussed more, mostly because there are so many other treatment options available.” Janki hears increasing numbers of callers to Glaucoma UK’s helpline asking whether their condition is lifelong, if they need to take eye drops for the rest of their lives and if there are any other options, “knowing that laser treatment and MIGS [minimally invasive glaucoma surgery] interventions might be possible”.
“When I am speaking to people on the helpline, my eyes are much more open to
Is it all getting too much?
The effort, cost and logistics of managing treatment for eye conditions can have a big impact on patients’ quality of life. Anna Scott explores what can be done to minimise their treatment burden.

12 Acuity WINTER 2023 BIG QUESTION
the quality of life that people have when we leave them with drops. There are far fewer patients that say to you in clinic: ‘I really don’t like doing this.’
“It’s only once you leave the patient on daily drops that they really start to ask, ‘What is glaucoma and what would happen if I just didn’t treat it?’”
ANXIETY IMPLICATIONS
A recent report by the Macular Society (2020) found that patients facing treatment for macular disease were suffering “significant burden”, including high levels of anxiety surrounding their appointments, and that 55% who were receiving treatment for wet age-related macular degeneration (AMD) admitted to feeling anxious “always” or “some of the time” before their appointments.
“In the survey, the feelings of anxiety did not change according to how long patients had been receiving their treatments, with half undergoing treatment for more than three years,” says Cathy Yelf, Chief Executive of the Macular Society. “This goes against the belief that over time
patients are likely to become less anxious, as they become accustomed to frequent anti-VEGF [vascular endothelial growth factors] injections. However, despite the burden, the majority of patients continue to attend their appointments, as losing their sight is not an option for them.”
Mike Horler FCOptom is Consultant Optometrist in Medical Retina at University Hospitals Sussex NHS Foundation Trust. “The mainstay of treatment for macular degeneration, diabetic macular oedema and retinal vein occlusion is regular injections into the eye,” he says. “There is a treatment burden for the patient: having to come in, every four weeks in some cases. Added to the anxiety of the treatment, we cover quite a wide geographic region. So some patients are having to travel up to two hours each time.
“Patients are often elderly, need help from family members or friends, and may need to use public/hospital transport and taxis or struggle to find parking. There may be comorbidities that mean they miss appointments because they are having other hospital treatment. What if they want to go on holiday? You can totally understand why patients feel ‘I just can’t go this week. I need a break,’ even though they know it’s potentially going to affect their vision.”
But even minor eye conditions may be prone to treatment burden. Dry eye, for example, doesn’t require clinical follow-up, but patients often present with the same complaint at their next check-up and it may be clear they have not used the drops prescribed or recommended to them.
What goes hand in hand with patients not adhering to their medication is guilt,
Reducing the burden for patients
● Ensure effective communication. Talk clearly to patients about their prognosis and what the treatment means. Follow up to ensure they are clear about both.
● Be aware of the range of services and information available to patients that you can signpost to them. Many charities offer helplines, counselling and guidance on practical issues of receiving treatment, and you can refer patients to them.
● Ask patients about transport. For example, if their bus pass doesn’t allow them to travel before 10am, they won’t be able to make a 9am appointment.
● Educate patients about potential side effects of treatment – for example, eye drops that change eye colour or encourage eyelash growth – so these things don’t come as a shock.
● If patients have carers, make sure that they too are fully informed and educated about the treatment regimen, side effects and the importance of treatment. Find out if they also need support.

● Make use of eye care liaison o cers (ECLOs, also known as eye clinic liaison o cers), who can support patients with eye drop aids and techniques for using their drops effectively. They can also provide patients with emotional support and signpost them to services available in the local area.
HELPLINES
Glaucoma UK: 01233 648170 helpline@glaucoma.uk
Macular Society: macularsociety.org
Macular Society Advice and Information Service: 0300 3030 111
RNIB Sight Loss Advice Service: 0303 123 9999
13 Acuity WINTER 2023 BIG QUESTION
Added to the anxiety of the treatment, some patients have to travel up to two hours each time
explains Patrick Gunn MCOptom, Principal Optometrist for Education and Training at the Manchester Royal Eye Hospital, as is wanting to avoid consultations or the discussion completely, leading to them dropping out of treatment entirely.
Other factors have an impact on treatment burden, such as medication supply and cost, says Patrick, citing the example of glaucoma. “It is a chronic condition that brings with it all kinds of challenges for patients, in terms of side effects of eye drops or difficulties instilling their medications,” he says.
“There are difficulties with supply from the GP. An increasingly problematic factor for patients is cost. Some simply can’t afford to pay for eye drops, either privately or on NHS prescription, because there are so many financial pressures.”
Another consideration is whether patients experiencing an improvement in their condition are less likely to experience treatment burden. Professor Robert Harper FCOptom, Optometrist Consultant at Manchester Royal Eye Hospital, says this comes down to the explanations people are provided with. “Unfortunately with glaucoma, for example, the treatment doesn’t make people better, it stops them getting worse,” he says. “There are people
The patient’s view

Maureen, in her 70s and diagnosed with wet AMD 17 years ago, has three antiVEGF injections every four weeks in her left eye.
“[The right eye] has so little sight in it, they can’t really do anything with it. But the consultant says it could be helped with laser treatment. I’m waiting to hear about that,” she says.

Maureen has had more than 70 injections since diagnosis. She also has follow-up scans. “I go to the local hospital, which either means two buses or a taxi. I also have a neighbour who sometimes takes me,” she says.
“But when I have to get a taxi it’s a bit problematic because obviously when I come out from having an injection I can’t really see anything, and the taxi drivers don’t really want to get out of the taxi [to find me].”
Generally, communication is straightforward – appointment letters for either the injections or follow-up scans and clear guidance given about her condition – but occasionally it isn’t apparent to Maureen why she






needs to go for an appointment. “I’ve had two letters recently that just give a date and time and the consultant’s name. I would assume it’s for laser treatment but I don’t know,” she says.

There’s also confusion about prognosis. “I was told about a year ago by one consultant that I may not have any more [injections] because I’ve got a lot of scarring, but then another consultant said I should have a set of four. And I thought to myself, ‘Do they not agree?’ I still don’t really know why.”
Cancellations can also be a problem. “You know the treatment isn’t very pleasant. You just want it to be over and done with,” she says. “You don’t want to be told to come back next week.’
But Maureen attends all her appointments. “I can’t say that my eyesight has improved – it’s gradually got worse.”

But she adds: ”I don’t know if it would have got even worse if I didn’t have the treatment.”



See page 28 for the second article in our ageing population series.

14 BIG QUESTION Acuity WINTER 2023
IMAGES: GETTY / ISTOCK
who want to stop using the drops because there has been no improvement. That’s when someone hasn’t been given adequate counsel.
“This is all part and parcel of expectations management and we need to have improved conversations and patient education to try to reduce the impact of that sort of effect on sticking with the treatment.”

SOLUTIONS TO THE PUZZLE




There’s also an impact on eye care practitioners and NHS budgets. NHS England hasn’t yet collated data on the impact of treatment burden on professional time, medication costs and budgets. One study calculated that the mean cost to the NHS of glaucoma treatment over the lifetime of a patient was £3,001, with an annual cost of £475 per patient, with non-drugs – including staff time spent on in- and out-patient appointments, procedures and equipment – comprising 66% of costs and drugs 34% (Rahman et al, 2012).
Treatments for macular disease represent some of the highest drug costs in secondary care, Cathy says. “Delivery of the treatment has to be in a clean room and, when first introduced, only ophthalmologists gave the injections,”

she says. “Such is the demand for treatment that nurses, orthoptists, optometrists and theatre technicians have all been recruited as injectors.”
According to Mike, “the main challenge for delivering eye care services is that it’s a big logistical puzzle – scheduling scans, injections and face-to-face appointments – especially when patients are being treated by a variety of clinicians.”
think it is also up to primary care optometrists. It’s up to GPs, pharmacists, and others, especially when patients are more vulnerable. And it starts at the time of diagnosis. Patients need to understand the diagnosis.”
Mike adds: “Optometrists are in a great place to educate their patients about the benefits of good diet, the risks of smoking and the other things that can affect the progression of a condition. They’re in a good place to refer appropriately as well.”
SUPPORTING PATIENTS
Education and support should be tailored for individuals – what works well for one person may not work for another. The glaucoma service in Manchester provides a patient support group and access to glaucoma support nurses for one-to-one advice. “Just having a variety of different options and making them available to patients is really important,” Patrick adds.
Effective communication with patients about the ongoing importance of treatment is crucial. “It is a whole eye care pathway responsibility,” says Robert. “We need to not see this as purely something that relates to clinicians seeing patients on the day in the clinic. I
Janki says the pandemic provided a learning curve for eye care practitioners about how little they could actually monitor patients’ treatment and condition when they weren’t able to see them. “We all have those patients who may not come to appointments but COVID-19 really showed how, when we can’t monitor patients, they can have quite a deterioration in a short space of time,” she says.
“Knowing that your patients fully understand what they’re taking, why they’re taking it and the condition they have, that they have got completely open communication, is really important.”

MEMBER RESOURCE




How to communicate effectively with patients: coptom.uk/3BUjOO5

There are people who want to stop using the drops because there has been no improvement
15 BIG QUESTION Acuity WINTER 2023
With a dynamic professional life that includes active interests in research, education and clinical work – not to mention her role as Clinical Lead for Ophthalmology at Central Middlesex Hospital and co-lead for the North West London Clinical Reference Group – it would be hard to imagine how Consultant Ophthalmologist Evelyn Mensah could fit much more into her life. But some issues, she says, are too important to ignore.
“If optometrists see anybody receiving any type of racism, they need to call it out. You can’t be bystanders; you need to be upstanders who are ready to challenge behaviours and take action.”
“May 2020 was something of a reckoning with the murder of George Floyd,” Evelyn says. “Because of that, and also because of what was happening to people across the world
, cal ed to be allen a eorg that, world































 Evelyn Mensah Consultant
Evelyn Mensah Consultant

Ophthalmologist, talks about the steps she is taking to encourage equity.
t e o o ce ace qu qua ty St S a da d [W [WRES] S expert fo f r Lond n on North Wes e t Un U ivversiity t Heaalt l hc h are e NH N S Tr Trus u t.







“Th “ e first NHS WRES report was pu p blisshehed d in n 201 0 6 wiith th data fr from the he 2015 annual NHS staff ff survey, and thhe e la lateest repport wa was s publblisishe h d in n March h witth data ta from m 20021. Almost
during the COVID-19 pandemic – and its disproportionate impact on different populations – I signed up to become the Workforce Race Equality Standard [WRES] expert for London North West University Healthcare NHS Trust. rst NHS WRES report was published in 2016 with data from the survey, and the latest report was published in March 2022 with data from 2021. Almost 50%
of NHS staff surveyed report personal discrimination experienced on the basis of their ethnic background. When you look at the trend over the past five years, this has worsened for racial discrimination when compared to other protected characteristics, which have improved.
t e t e d o e t e past e yea s, e discrimination wh co c mparred e to ot othe h r prrottected d ch c araccte t risticcs, s which have d

“SSo o th the po p innt t of o the he WRES S pr p ograamm m e is s to ensure e that Black, Asian annd minority et e hnnic c stataff havve e eq e uaal l ac access s to o career er and receive fair treatme m nt in









“So the point of the WRES programme is to ensure that Black, Asian and minority ethnic NHS staff have equal access to career opportunities and receive fair treatment in













A RECKONING WITH RACISM


ps
16 ONE TO ONE Acuity WINTER 2023
The greatest gift: what it takes to be a surgeon
Her mother was a pattern cutter and, from an early age, Evelyn learnt the value of precise handiwork. But that is just one skill an ophthalmic surgeon needs.
“I do some of the most complex and di cult cataract surgeries using just topical anaesthesia, and probably the most rewarding part of my professional life is teaching my trainees to do topical cataract surgery. There’s nothing wrong with blocking, but when you train using just anaesthetic drops and a bit of anaesthetic inside the eye, it teaches you how to handle eye tissues with care,” she says.
“It also teaches you important communication skills because that patient is awake. I show my trainees how to speak with the patient, how to treat the patient holistically. You’re looking at their anxiety levels. You’re being compassionate, empathetic, gentle. You’re reassuring them while you’re treating them. I really do believe that eyesight is the greatest gift we can give, and I just adore training others to do it.”
the workplace, looking at nine general key indicators [see Member resource].”
WIDER EFFECTS
Race is one of the key social determinants of health outcomes. Evelyn says that, if we can reach the stage where everyone has the same experience, whether they are from an ethnic minority or not, we will have a healthier NHS workforce and better cared-for patients. In her own area of specialism – ophthalmology – there is obvious work to do.
“Nobody has looked into the experience of ophthalmology patients in a disaggregated way, in terms of their care and outcome with respect to race,” Evelyn says.

“London is one of the most diverse places in the country and we know that there are certain eye conditions that impact some populations more than others. For example, diabetic retinopathy, glaucoma or sickle cell retinopathy predominantly impact specific groups of people. But there is very little research regarding individualised treatment according to race.
“For example, somebody who is suffering with diabetic macular oedema can receive very effective treatment with an injection of anti-VEGF [vascular endothelial growth factor] agent. To be able to start the treatment in England, according to NICE guidelines, you have to


have a central retinal thickness of at least 400μm. However, there is evidence that macular thickness is smallest in Black people, followed by Asian people, when compared with Caucasians. That means Black people are already disadvantaged and would require a much greater volume of macular fluid before being able to start treatment. That is a racial disparity in itself.”





INTERNATIONAL INFLUENCE
Locally, Evelyn has been working with her trust to examine their Medical Workforce Race Equality Standard (MWRES) data in a uniquely localised quantitative and qualitative way to understand the lived experience of minoritised staff. Nationally, she has run a webinar for the Royal College of Ophthalmologists in August 2020 looking at racism in the NHS, and she was invited to host the EDI session at this year’s Royal College congress in Glasgow. Evelyn is also working with the Royal College Council to improve diversity and educational attainment.
But her international efforts aren’t confined just to WRES. As a trustee of the Moorfields Lions Korle Bu Trust, Evelyn has been one of the driving forces helping to deliver medical retina (MR) subspeciality training to ophthalmic surgeons in West Africa.
“The training, which we developed in

partnership with our West African colleagues, is a two-week residential course in Ghana following online pre-course learning, with candidates selected from the West African College of Surgeons. We ran the first MR course in December 2016, and one of the candidates from that course actually became a trainer for the second course in 2018.
“I didn’t need to attend the third and fourth MR courses in 2020 and 2021, because the system had become selfsufficient. I taught with West African trainers during the fifth MR course in 2022 and was delighted with progress. Training, educating and passing on that knowledge is far more impactful than just having people like me going out to provide clinical care.”
Now Evelyn is keen to develop another project that could impact the way ophthalmologists treat patients.
“One area I’m passionate about is sickle cell retinopathy [SCR]. There has been hardly any research into it. The last randomised controlled trial looking into laser treatment for SCR was in Jamaica in the 1990s. Even though it demonstrated that treating early with lasers reduces subsequent vitreous haemorrhage, people are still undecided about the optimum time to treat it,” she says.
“One of the reasons I was so interested in the training programme in West Africa is because ophthalmologists there see far more patients with SCR than anywhere else in the world. So why aren’t we forming a network with our ophthalmology colleagues there? That’s something I really want to do – form a network for the management of SCR and find the best way to reduce its morbidity.
“For the first time, I want to see my West African colleagues leading on this work and providing expert knowledge to the rest of the world.”
INTERVIEW: MATT LAMY IMAGES: GETTY / RICHARD H SMITH
MEMBER RESOURCE WRES
17 ONE TO ONE Acuity WINTER 2023
indicators: bit.ly/3Ck06vi

18 SCREEN TIME Acuity WINTER 2023
Helen Gilbert reports.

When COVID-19 sparked worldwide lockdowns in 2020, screen time among children and adolescents soared as they relied on computers and tablets to keep up with their education at home.




Primary school children aged six to 10 recorded the largest increases in screen usage, averaging an extra 83 minutes a day, while screen time rose by 55 minutes for those aged 11 to 17 and by 35 minutes for under-fives, a global analysis of 89 studies found (Trott et al, 2022). Leisure screen time (time not used for work or study) also increased for all age groups, said researchers at the Vision and Eye Research Institute at Anglia Ruskin University (ARU), which conducted the review.
The study, described by senior author Professor Shahina Pardhan MCOptom, Director of ARU’s Vision and Eye Research Institute, as “the first of its kind to look systematically at peer-reviewed research


Is increased screen time causing visual and eye health problems in children?
19 Acuity WINTER 2023 SCREEN TIME
papers on increases in screen time during the pandemic and its impact”, also found leisure screen time climbed for all age groups.
RISING SCREEN TIME
In the UK, 15- to 16-year-olds spent an average of four hours and 54 minutes on screens each day in 2020 (Ofcom, 2021). And in the US, there was an almost 500% increase on pre-pandemic levels, with nearly half of children aged five to 15 clocking up more than six hours each day (ParentsTogether, 2020).
The report warned that the long-term effects of this reliance on technology and screens remains unknown: “The pandemic’s influence on Generation Z [born in the mid- to late 1990s] and Alpha [born in the early 2010s onward], the youngest generations during coronavirus times, will not fully be seen for years to come.”
So should optometrists be worried? Is extended screen time having a detrimental effect on children’s eyesight, and do limits need to be imposed?
When the Royal College of Paediatrics and Child Health (RCPCH) published its screen-time guidance, it said there was not enough evidence to confirm the activity was in itself harmful to child health at any age, making it impossible to recommend age-appropriate time limits (RCPCH, 2019). But that was before the pandemic struck, and before children were increasingly using screens for home schooling.
DIGITAL EYE STRAIN
Shahina said their global analysis of screen-time habits (Trott et al, 2022) discovered associations of screen time with poor eye health, including digital eye strain in children as well as inferior diet, deteriorating mental health (including anxiety) and behavioural problems such as aggression, irritability and the increased frequency of temper tantrums. Primary school-aged children increased their screen time by the most (1.4 hours),
followed by adults (one hour), and adolescents (0.9 hours). “As with any study of this type there are degrees of variability between all the research we looked at,” Shahina notes.
“However, the overall picture provides support that excessive screen time should be reduced wherever possible to minimise potential negative outcomes.”
HIDDEN ISSUES
Another review by Shahina and colleagues identified digital eye strain, often characterised by eye discomfort during or after device use, blurred vision and headaches as a risk of increased screen time (Pardhan et al, 2022).
Unstable binocular vision and dry eyes were also associated with the excessive use of screens. Furthermore, any uncorrected refractive errors that were previously tolerated, such as hyperopia, may manifest themselves more readily with increased screen time, the paper stated.
It is important to make sure that children attend their local optometrist for regular eye examinations, the authors wrote. If binocular vision is unstable, there is also an increased risk of blur, double vision and eye strain as the eye muscles constantly try to realign the eyes.
Simon Frackiewicz MCOptom, of Robert Frith Optometrists in Yeovil and Chard, Somerset, and an orthoptist and optometrist at Yeovil District Hospital, explains that excessive screen time itself is unlikely to cause changes to binocular vision, but cautions that it is very likely to exacerbate underlying conditions.
“Under normal circumstances, a child’s visual world would be dynamic and their focus would change from near to distance as they look from their work to the board, for example,” he says.
“If this environment is suddenly changed for a computer screen, then they will be required to hold sustained focus at

Tethered to tech? How optometry should adapt
Neil Retallic MCOptom, President of the British Contact Lens Association, says it has become more commonplace in practice to ask patients, including children, comprehensive questions on digital device usage and any associated symptoms. Patient management systems are also increasingly including pre-populated fields on these aspects too.
“The appreciation of the benefits of a detailed slit lamp examination in children is becoming the norm over using direct ophthalmoscopy techniques,” he says.
“Conducting a more detailed ocular surface assessment is anecdotally being reported, especially in those considered at higher risk of eye health changes due to digital device usage.
“While spectacles or contact lenses are likely to help relieve symptoms of digital eye strain linked to uncorrected refractive error, there is evidence that contact lenses can adversely impact changes in blinking behaviours that are both shortand long-term risk factors for tear film and meibomian gland changes.”
Acuity WINTER 2023 20 SCREEN TIME
Excessive screen time should be reduced to minimise potential negative outcomes
a short distance, without the natural breaks to look further away, which may cause eye strain and headaches.”

COMMUNICATION CHALLENGES
“Children may find it harder to communicate their symptoms compared with adults, which may subsequently have a prolonged impact on their ability to engage with their schoolwork,” Simon adds. Children may suffer from sleeplessness, sore eyes or a loss of social connection (RCPCH, 2019).
Dr Jignasa Mehta, Professional Lead for Orthoptics at the University of Liverpool, says it is important to detect binocular vision changes early. “In young children, where their visual system is developing (up to the age of seven or eight), a change in visual status can potentially lead to suppression of one eye so that they no longer have binocular vision or have impaired binocular vision,” she explains.
“This can impact on their ability to appreciate depth and they may develop double vision. They may also complain of headaches and discomfort.”
Professor James Wolffsohn FCOptom, Head of the School of Optometry at Aston University, says there is little evidence that binocular vision exercises help to relieve digital eye strain. “A full refractive correction, a decent night’s sleep, advice on full and regular blinking, a good diet particularly rich in omega-3 and regular breaks are the key mitigation aspects.”
LIFESTYLE HABITS
Pardhan et al (2022) also highlighted a tendency in children and adolescents to use several devices at the same time.
It cited a UK-based study of 816 12to 13-year-olds that reported 59% using more than one screen simultaneously after school, 65% using at least two screens together in the evening, 36% before bed and 68% at weekends (Harrington et al, 2021).
Best practice tips
Neil Retallic MCOptom says:
● Employ careful questioning. Ask about smart or digital device use rather than just computer use as this will provide a more accurate picture.
● Imaging devices allow for high-quality meibography assessment. Grading the quality and quantity including gland expression is beneficial.


● Look out for signs of telangiectasia, hyperemia, capping and anatomical distortions of the eyelid and meibomian gland atrophy.
● Suggest interventions such as the 20:20:20 rule (every 20 minutes look at something 20 feet away for at least 20 seconds) and regular breaks, and fully correct refractive errors.
● Consider the most effective ways of communicating these points of best practice among staff and motivating them to apply them. This is especially important given the typical initial asymptomatic presentation in the early phases.
The very act of flitting between different devices increases eye strain by 22%, says Shahina, as it entails switching distances and adjusting the accommodative power of the eyes between different devices.

The paper also suggested that smartphones and tablets viewed at shorter distances, between 20cm and 40cm, where the screen and font sizes are generally much smaller than that of a desktop computer, also result in the need for more accommodative power in the eye and a higher risk of eye strain.



Unsurprisingly, dry eye is another hazard of increased screen time. A secondary analysis of a large crosssectional study investigated the impact of digital screen use and lifestyle factors on dry eye disease within the paediatric age group (five to 16) and found that greater

digital screen exposure was a risk factor for dry eye disease, while sleep was a protective factor (Wang et al, 2022).

BLINKING PATTERNS

Meibomian gland dysfunction (MGD) is a primary cause of dry eye disease, which can lead to discomfort due to the anterior eye drying out, especially with reduced blinking during periods of concentration.





There are approximately 30 to 40 meibomian glands (MGs) in the upper eyelid and 20 to 30 in the lower eyelid. The meibum secreted by the MGs is a vital component of the tear film, stabilising it and increasing tear film break-up time. If the quality or quantity of meibum changes, this can lead to ocular and eyelid discomfort, ocular surface disease, and evaporative dry eye (Khan et al, 2021).

Acuity WINTER 2023 21 SCREEN TIME
One study examined the effect of smartphone use on blinking and tear film function in children aged five to 16 years (Chidi-Egboka et al, 2022). Researchers found the blink rate reduced from 20.8 blinks per minute to 8.9 when children played games on a smartphone continuously for one hour. They concluded that smartphone use resulted in dry eye symptoms, despite no change in tear function evident for up to one hour.
“Given the ubiquitous use of smartphones by children, future work should examine whether effects reported herein persist or get worse over the longer term, causing cumulative damage to the ocular surface,” the authors wrote.
Extended screen time among young people was also associated with blinking behaviour consistent with patients with dry eye (Muntz et al, 2022).
James Wolffsohn, one of this study’s authors, says: “We know that digital eye strain also increases with screen time, with every additional hour/day increasing the risk of dry eye by 15%. Digital eye strain has been linked to both dry eye disease and binocular vision problems, but the balance between cause and effect is not known.”
Implementing routine clinical screening, educational interventions and developing official guidance on safe screen use may help prevent an accelerated degradation of ocular surface health and quality of life in young people, the paper concluded.
Simon notes that children, as a cohort, are in some ways more vulnerable to the effects of reduced blinking (tear evaporation, dry eye and potential inflammation of the ocular surface): “They are likely to be exposed to excessive screen use for many more years, given the ways that education and the workplace have changed in recent decades.”
A US study evaluated 172 children and discovered that excessive electronic screen use among children was associated with severe meibomian gland atrophy (MGA) (Cremers et al, 2021).
All severe cases of MGA had ocular symptoms/signs of dry eye disease,
View on the ground
Simon Frackiewicz MCOptom, Paediatric Optometrist at Yeovil District Hospital, says:
In practice, I am seeing an increase in the number of young people with symptoms consistent with dry eye syndrome, which seems to have risen further since the pandemic.
This is no coincidence, given how devices have become more widely used in the academic environment. The cohort of children attending our department typically comprises those with visible issues, such as squints, or those referred from school screening with reduced vision.
As such, the mix of refractive errors tends to be hyperopia, anisometropia and astigmatism. I would expect to see a small number of myopes referred through school screening, but this number has certainly increased in the past few years. There seems to be a fairly clear link between these myopes and excessive use of mobile phones and tablets.
There is also a definite increase in the number of younger patients presenting with symptoms of eye strain who struggle to cope with relatively small amounts of hyperopia or ocular misalignment. I have no doubt that this is the result of the increased visual demands in the modern education system. In addition to increasing amounts of myopia, I find more children are experiencing eye strain and benefit from relatively small prescriptions.
including corneal neovascularisation (29%), best-corrected visual acuity loss (41%) and central corneal neovascularisation (14%), and 86% reported four hours or more of daily screen use, while 50% were on screens for eight hours plus a day. The authors concluded that further research was needed to establish formal electronic screen use limits based on meibography grade and to evaluate correlation of autoimmune disease biomarker positivity in children with severe MGA.
Interestingly, research investigating the prevalence of MGA and gland tortuosity in the paediatric population reported mild asymptomatic levels of MGA as relatively common in the young – 42% of subjects had evidence of MGA and 37% indicated meibomian gland tortuosity (Gupta et al, 2018). It also discovered moderate-severe gland atrophy to be present.
“This calls into question our current understanding of baseline gland architecture and suggests that perhaps clinicians should be examining young patients for meibomian gland dysfunction and atrophy because it may have implications for future development of dry eye disease treatment,” the study stated.

FURTHER STUDIES
What can optometrists learn from this? The latest evidence certainly suggests that extended screen time during childhood points to increased digital eye strain, with reduced blinking making children more susceptible to blurry vision and headaches.
Shahina says the next research step would require investigating how a reduction in increased screen time would impact eye health, myopia and the wellbeing of children. In the meantime, parents and teachers have a role to play in helping children use technology responsibly, while optometrists can offer advice and be alert for – and correct – any potential eye or vision problems that may present earlier but traditionally may have taken longer to identify in children.

IMAGES: GETTY
Acuity WINTER 2023 22 SCREEN TIME
The WONDERS of the
CORNEA

Brush up your knowledge on one of the most remarkable parts of the eye. Kimi Chaddah explores the cornea’s anatomy, its capacity for healing, and promising research avenues in corneal innervation.
orneal innervation is an increasingly exciting avenue in medicine.
Examining the innervation of the cornea is beginning to be applied in new ways to understand ocular-specific and systemic diseases, from diabetes to cancer.
As the body’s most sensitive tissue, the cornea is the most densely innervated part of the body (Yang et al, 2018), receiving innervation solely from nociceptive neurons (which cause us to sense pain after physical damage). Sensory nerve endings in the corneal epithelium have a density around 400 times greater than those in the epidermis of the skin,
CPD AVAILABLE ONLINE Acuity WINTER 2023 23 REFRESHER
IMAGE: SCIENCE PHOTO LIBRARY
C
with approximately 7,000 nociceptors per square millimetre in the cornea (Remington, 2012).
The cornea’s principal function is helping the eye to focus entering light – the cornea alone provides 65% to 75% of the eye’s total focusing power (Heiting, 2022). The cornea enables light rays to be focused on the retina with as little scatter and optical degradation as possible, and protects structures existing inside the eye.
“The cornea is largely made of collagen, which gives it strength and resistance to injury – though it’s not completely impenetrable,” explains Professor Mark Bullimore MCOptom, a scientist, speaker and educator based in Boulder, Colorado, with a PhD in vision science. “The cornea is rendered transparent by the regularity of the stromal fibres, which allows light to pass through relatively unobstructed,” he adds. “This is in contrast to the sclera, where collagen fibres are arranged much more randomly, and which is therefore opaque.”
In contrast to other bodily tissues – and other areas of the human eye – the cornea has no blood vessels. In order to refract and allow the passage of light, the cornea must be transparent.
The cornea’s features carry deeper significance. “The cornea is exquisitely clever at preventing eye infections,” says Professor Lyndon Jones FCOptom, Director of the Centre for Ocular Research and Education at the University of Waterloo in Canada. Overlying the cornea is a layer of mucin produced by goblet cells that provides protection and allows the tear film to adhere, while the closely packed epithelium forms a latticework that also prevents access to the inside of the eye.
“Tear film has lots of antibacterial enzymes in it, particularly lysozyme,” explains Lyndon. “Should bacteria contact the surface of your eye, lysozyme is very good at killing those bugs.” The blink mechanism also serves as a physical barrier against bacteria, and the epithelium safeguards the rest of the
eye from dust, germs and harmful particles.
“The cornea is a fairly stable structure – while other parts of the body grow or elongate, the cornea remains fairly constant,” says Mark. But in some cases, the cornea may become damaged. When damage to corneal nerves in the central cornea does occur, the normal nerve pattern typically presents by week four. However, the reinnervation of peripheral branches can take longer than 60 days, culminating in a less dense nerve network with lower density than that of the normal cornea.
In vivo confocal microscopy (IVCM), which is frequently used to study the cornea at a cellular level, has been used to diagnose and assess the progression of diabetic neuropathy (Misra et al, 2022). In evaluating corneal innervation, IVCM is also able to detect corneal nerve abnormalities, which may be present in various ocular and systemic conditions such as dry eye disease, glaucoma, diabetes and migraine, where decreased corneal nerve density and sensitivity have been observed (Patel et al, 2021).
CHANGES TO THE CORNEA
“Pathophysiological changes to the cornea will depend on the type of damage and which level of the cornea is affected,” explains Don Williams FCOptom, the first optometrist in the UK to gain formal accreditation in laser procedures.
When corneal nerves are damaged
as a result of disease, surgery or trauma, this can lead to diminished corneal sensitivity, epithelial defects and possible visual impairment, creating eye pain, light sensitivity, inflammation and fatigue.
After an epithelial abrasion, the corneal epithelium usually renews itself rapidly, typically repairing in 24 to 48 hours in the majority of cases.
“Corneal healing is mainly dictated by four main processes: cellular migration, proliferation, differentiation and extracellular matrix remodelling,” says Don. “Any trauma that disrupts one or more of these healing processes will cause either temporary or, in more severe cases, permanent damage to the cornea.”

POST-REFRACTIVE SURGERY
“As a general rule, any refractive surgical procedure will cause trauma to one or more of the corneal layers,” says Don. “As our understanding of corneal response post-refractive surgery improves, it is becoming clearer that stromal keratocytes play a crucial role in defining the result of refractive surgery.”
Photorefractive keratectomy, or PRK, aims to correct vision, including myopia, hyperopia and astigmatism. Unlike Lasik procedures, the most-performed refractive surgery in the UK, PRK does not leave an
The cornea: Fast facts
● The cornea is 300 to 600 times more sensitive than the skin.
● The cornea is one of the fastest healing parts of the body.
● Corneal sensory nerves have a neurotrophic effect, influencing corneal metabolism and aiding in tissue maintenance.
● The cornea in a young person prevents over 90% of UVB and 45% of UVA from reaching the posterior structures of the eye.
(Rosenblatt et al, 2020; Delic et al, 2017; Remington, 2012)
IMAGE: SCIENCE PHOTO LIBRARY 24 REFRESHER Acuity WINTER 2023
epithelial flap in the cornea, which may result in an increased risk of complications should an infection or injury to the eye occur.
“Histologic studies have reported an increase in the epithelial thickness (hyperplasia) following PRK,” says Don. “Failure to re-establish a normal epithelial basement membrane to promote firm epithelial reattachment contributes to epithelial breakdown [Chao et al, 2014].
“It’s not uncommon for PRK patients to report symptoms of dryness and foreign body sensation suggestive of subclinical corneal erosion.”
Almost half the patients who have Lasik experience dry eye after the surgery, with evidence indicating that this can be attributed to alteration of corneal innervation (Chao et al, 2014). “Lasik uses an excimer laser to remove tissue from the cornea through a process of photoablation,” explains Don. “Stromal and sub-basal nerve damage occurs during flap creation and the excimer stromal ablation – and damage to these sensory nerve fibres of the cornea decreases basal and reflex tearing, slows the blink rate, decreases corneal sensation and impairs neurotrophic effect of the corneal epithelial cells.”
CATARACT SURGERY
“In cataract surgery, you make a small – 2mm to 2.2mm – incision to the cornea,” says Samer Hamada, an ophthalmic surgeon at Queen Victoria Hospital NHS Foundation Trust.
“Corneal wound repair after cataract surgery is complex and facilitated by fibroblasts – if not optimised, it can lead to the distortion of the cornea and the creation of new refractive error, such as astigmatism – which might affect final visual outcomes after cataract surgery,” he explains.
“Secondly, damage to the endothelial layer of the cornea can lead to cornea swelling, particularly around the main incision area. A more severe form of corneal endothelial damage would lead
Layers of the cornea
The cornea is traditionally considered to contain five layers: the epithelium, Bowman’s membrane, the stroma, Descemet’s membrane and the endothelium. A potential sixth pre-Descemet’s (sub) layer (Dua’s layer) has been recently identified (Dua et al, 2013).
● Epithelium: a regenerative layer that covers the front of the cornea.
● Bowman’s membrane: the basement membrane of the epithelium, comprising collagen fibres, a protein that structurally reinforces the cornea.
● Stroma: provides mechanical strength to the cornea, maintains corneal transparency and serves as the main refractive component of the cornea. The stroma makes up 80% to 85% of corneal thickness.
● Descemet’s membrane: a relatively transparent matrix serving as the basement membrane of the endothelium.
● The endothelium: a single layer of specialised cells responsible for corneal clarity by removing water from the corneal stroma.
to corneal decompensation or failure where the cornea becomes swollen and loses its transparency.”
While corneal sensitivity may deteriorate after long-term contact lens (CL) wear, this change in sensitivity does not appear to be correlated with an alteration in the number of nerve fibre bundles in the sub-basal plexus of the cornea. “The worst-case scenario for a CL wearer and for the CL clinician is to have a patient who has an infection, such as microbial keratitis,” says Lyndon, with unpermitted sleeping in CLs being the main risk factor.
NEW POSSIBILITIES
But the cornea has opened up new realms of possibility in the medical world. Corneal innervation can be measured in a noninvasive manner, rendering it a possible surrogate biomarker useful for skin biopsy
measurements. Because of this feature, Ferrari et al (2013) compared hindpawskin and cornea innervation in mice exposed to neurotoxic chemotherapy. Both tissues exhibited highly correlated and dose-dependent nerve fibre damage, indicating that corneal nerves can potentially serve as a surrogate marker for skin peripheral innervation.
“There’s a lot of interest in using CLs and interacting with the ocular surface in some way to be able to detect ocular disease and systemic diseases,” says Lyndon. The composition of the tear film is of particular interest, including a variety of features that may be of interest when looking at systemic diseases. “Glucose in the tear film can be used to estimate glucose levels in the blood, which determines diabetes.”
Meanwhile, the presence of cancer markers on the tear film – as well as markers of Alzheimer’s disease – speaks to the potential opportunities for biomarkers in the tear film to indicate systemic disease. “The growing interest in tear film biomarkers will hopefully enable smart CLs to detect these biomarkers and provide valuable information about a variety of systemic diseases,” says Lyndon.
The potential future applications for studying corneal innervation are vast. The cornea is a vital part of the eye, and more exciting avenues concerning corneal innervation are continuing to emerge.
25 REFRESHER Acuity WINTER 2023
After an epithelial abrasion, the corneal epithelium usually renews itself rapidly
n recent years, optometrists across the UK have been increasingly involved in providing eye care over and above routine eye examinations in many settings, including primary and secondary care. While this has been driven by the need to manage the increasing demand and pressures on NHS services (exacerbated by the COVID-19 pandemic), it also reflects the willingness and desire of optometrists to demonstrate to their patients their role as clinicians first and foremost – and that they are more than capable of managing more complex patient needs.
For me, as an independent prescribing (IP) optometrist, it has led to even greater professional satisfaction to provide more care locally, quickly and often without the need to refer. This has the benefits of improved patient satisfaction within the practice and improved knowledge of the profiles and capabilities of optometrists more widely. This is critical in educating the public to recognise that optometrists should be their first point of contact when it comes to any eye problem they may experience, while helping to ensure appropriate signposting by other clinicians. Indeed, it is not uncommon for patients to approach their GP or
pharmacist before attending their optometrist, where the original problem could have been addressed more quickly.

Several studies have investigated the clinical decision-making of IP optometrists in eye casualty, where diagnosis, prescribing decisions and management advice/planning was compared to those of their ophthalmologist colleagues – statistical metrics for assessing agreement was very good in each domain, thus validating their ability to manage high-risk cases (Todd et al, 2020; Hau et al, 2007).
But what of the evidence for primary care or community settings? How do we know that patients’ needs are being safely and effectively managed here? Reports of locally commissioned urgent or emergency eye care service evaluations are convincing – a recent study published in the College’s own journal Ophthalmic and Physiological Optics showed that local practice-based IP optometrists were able to successfully manage patients to resolution in the majority of cases, resulting in reduced

BROAD
I Acuity WINTER 2023 26 CLINICAL
Dr Paramdeep Bilkhu MCOptom, Clinical Adviser for the College, on the scope of practice and eye care services in optometry practices.
NOTES
onward referral to local hospital eye service (HES) departments (Cottrell et al, 2022).
Likewise, these results were also observed in a community-based acute ophthalmology service delivered by specially-trained IP optometrists, where only 4% of cases were referred to the local HES (Ansari et al, 2022). In a literature review of locally commissioned enhanced eye care services (including those for cataract, glaucoma and red eye), the authors found that patient satisfaction was high with appropriately trained optometrists able to safely deliver clinically effective care (Baker et al, 2016).
While there are limited cost-effectiveness evaluations (Baker et al, 2016), these studies, together with other successful examples of local eye care provision (Konstantakopoulou et al, 2018), including during the COVID-19 pandemic (Kanabar et al, 2022), provide robust support for maintaining and growing commissioned eye care services (Williams et al, 2022), further recognising optometrists as important clinicians with decisionmaking capability and thus helping tackle the burden on the NHS.
EXPANDING YOUR SKILL-SET


These studies should also encourage optometrists to recognise that they can make a significant positive impact on their
local community and feel confident that they can do more. However, I am often asked by members how they can start to offer more for their patients, even though they may already possess higher qualifications. I reply by saying that obtaining a relevant qualification is typically only the first part of the puzzle. In addition to improving their knowledge, they also need to gain experience and skills to perform or offer investigations or treatments competently – to increase their scope of practice beyond core competency safely. As a health professional it is essential to recognise your own scope of practice, which will vary from one clinician to another. While this may appear challenging, I would argue that optometrists are already equipped with the tools to do so by engaging with reflective learning through regular clinical audits and CPD activities such as peer discussion.
To offer eye care above your current scope of practice, recognising your abilities and identifying any gaps in knowledge, skills and experience in order to provide additional eye care activity is an important first step towards creating an action plan to address these gaps. The College has recently published new guidance on expanding scope of practice, setting out eight key principles you should consider and reflect on to help ensure you can do so safely and effectively.
Expanded roles within the HES have taken and are continuing to take place, with optometrists typically undertaking local training and accreditation to perform roles such as intravitreal injections and specific laser procedures that would otherwise usually be undertaken by our medical colleagues (Gunn et al, 2022).
It is hard to escape the observation that an increasingly capable workforce through an expanded scope of practice, supported by the available evidence, is critical to delivering eye care to an increasingly complex patient mix – ultimately broadening the type and scope of eye care available locally and improving patient outcomes and experience. Moreover, I believe this will almost certainly lend itself to better job satisfaction by helping to fulfil the desire to serve our patients’ clinical needs better.
HORIZONS
COLLEGE RESOURCES
Expanding scope of practice principles for optometrists: coptom.uk/3hGEySy Clinical audit in optometric practice: coptom.uk/3PIX4pT
Exp x for or Cli Cl C n cop







IMAGE: GETTY
As a health professional it is essential to recognise your own scope of practice
Acuity WINTER 2023 27 CLINICAL
NOTES
rian Brown, 79, was diagnosed with wet agerelated macular degeneration (AMD) 10 years ago. “I used to be a table tennis player, but I couldn’t see the ball or the lines on the table any more, so I had to stop. And I’ve been unable to drive for the last year, as I cannot read a licence plate up to 20 metres away. Giving up my driving licence has been difficult to accept.”
In the second part of our series looking at the impact of ageing, Léa Surugue asks how to support older patients whose quality of life has been affected by age-related eye disease, and reviews the treatments available.

BLiving with his wife in High Wycombe and volunteering as treasurer of the local Macular Society group, Brian still leads an active social life. But his condition has affected his independence. To get into the clinic every six weeks for his anti-VEGF (vascular endothelial growth factors) injection, he must now take a taxi or rely on his son to drive him.
It’s surely not an unusual story, particularly since wet AMD is just one of the eye diseases affecting older people. A US study estimated that 57.5 million people worldwide are affected by primary open-
angle glaucoma. By 2020, it is expected that around 76 million people will suffer from glaucoma, a number estimated to reach 111.8 million by 2040 (Allison et al, 2020). Meanwhile, a worldwide study found that, in 2010, cataract was the cause of sight loss for one in three blind people, and the cause of visual impairment for one in six visually impaired people (Khairallah et al, 2015).
Losing sight, especially at an age where independent living may already be more complicated by comorbidities, can have a significant impact on quality of life, with repercussions on physical and mental
Acuity WINTER 2023 IMAGES: ISTOCK 28 AGEING
wellbeing, as well as on social life and family – an estimated five million (or 40%) of UK grandparents are relied upon to provide regular childcare for their grandchildren (Age UK, 2017). Many older people struggle to live with eye disease. Daily activities, the ability to take care of themselves and even to live independently are sometimes threatened, which also impacts on their wider families.
CLEARER PICTURE
Lately, studies to obtain objective data regarding the experiences and the

Ageing and eye health series
challenges of older people with an eye condition have been conducted. Access to this data is necessary if we are to develop solutions to improve patients’ quality of life based on their actual needs – and allow as many people as possible to continue carrying out their daily activities independently.
Driving, for example – which became an insuperable challenge for Brian – is an issue that is taken seriously by the College. Not being able to drive due to eye conditions limits patients’ independence. And if they continue driving, the risks may be high.
A report by the College, Visual impairment and road safety among older road users (see College resources), suggests an association between injury-collisions and visual impairment and health.
“Our report shows that drivers over the age of 60 are more likely to be involved in an injury-collision where visual impairment or illness and disability is reported as a contributory factor,” says Michael Bowen, Director of Knowledge and Research at the College.
The report stresses that, if optometrists can more actively support and empower
29 AGEING Acuity WINTER 2023
Lifestyle advice for older patients
Domiciliary optometrist Tracey Gauld MCOptom says: “In a domiciliary environment, you have an opportunity to see how a patient is living and observe the daily challenges that they might face. The following list of lifestyle advice is not exhaustive, but it may be helpful for someone living with vision loss.”
● USE UV COATING AND TINTED LENSES.
UV filters have a protective e ect for cataract development and AMD, and tints can make vision more comfortable.
● LIGHTING. Demonstrating with a torch or lamp can show what a di erence good light makes to seeing most things.
● CONTRAST AND COLOURS. Contrast is necessary to distinguish objects in di erent aspects of life, so playing around with colours can be helpful. For example, if a patient keeps walking into door frames or furniture, coloured or contrasting tape can be helpful to show where the edges are. If eating and drinking are a problem, go for plates that contrast in colour with the table around them and the food on them.
their patients to make informed decisions about driving and vision, this will encourage safer driving and help drivers maintain independence throughout older age, therefore improving their quality of life.
Other research has also focused on the risk of falls, which may increase for older people when they have an eye condition, and hence worsens their quality of life. A recent US study concluded that the prevalence of falls, fear of falling and activity limitation because of this fear was high in older adults with selfreported visual impairment (Ehrlich et al, 2019).
Considering falls are usually associated with fractures and thus pose a serious risk to the physical health of older adults and to their ability to live independently, delving deeper into the association between eye health and falls is a priority.
● SMOKING CESSATION. Current smokers are up to four times more likely to have AMD than people who have never smoked and are likely to get it earlier than non-smokers (Macular Society, 2022).
ADVANCING TREATMENTS
Visual impairment is a risk factor associated with a number of other adverse physical and mental health outcomes, such as cognitive decline, reduced physical activity, depression and frailty (Varadaraj et al, 2022). Social isolation and economic problems are also often reported in older populations affected by eye conditions (Yorgason et al, 2022).
“With loss of sight, a person’s world becomes a smaller and more anxious place to be,” says Tracey Gauld MCOptom, a domiciliary optometrist based in London. “Post becomes more difficult to read, so it might become harder to manage finances and bills. Difficulty reading newspapers reduces access to information about the outside world.
“Affected people may have difficulty carrying out everyday tasks, such as cooking and cleaning for themselves and
● LIFESTYLE ADVICE. Optometrists can also advise on eating green leafy vegetables, fish, broccoli, fruit, nuts and so on, and it is worth discussing supplements for AMD when appropriate. Other lifestyle advice includes keeping active when possible.
maintaining personal hygiene. Medicine labels become difficult to see.”
Not all eye conditions associated with old age can be easily treated – but scientists are working on it. “Exciting research is being carried out to improve the glaucoma situation,” says David Garway-Heath, Glaucoma UK Professor of Ophthalmology at University College London. “Publications are also accumulating that show poor mitochondrial function in glaucoma, and our group has published a study suggesting that good mitochondrial function is protective of glaucoma development in the presence of high eye pressure [Lascaratos et al, 2015].”
Meanwhile, a new drug for cataract is giving hope for future treatment of the condition. In laboratory trials, treatment with the oxysterol compound VP1-001 showed an improvement in refractive index
Acuity WINTER 2023 30
AGEING
profiles in 61% of lenses (Wang et al, 2022). Lead author Professor Barbara Pierscionek at Anglia Ruskin University called the finding “a significant step forward towards treating this extremely common condition with drugs rather than surgery”.
Anti-VEGF injections have transformed the treatment for wet AMD, but the need to return to a clinic repeatedly for injections – sometimes as frequently as every four weeks – can be burdensome for patients (see Big question on page 12). However, promising new anti-VEGF drugs that require less frequent injections have been introduced.
“Vabysmo [faricimab] could potentially see patients go up to 16 weeks between injections,” Cathy Yelf, Chief Executive at the Macular Society, says. “This will make a significant difference to patients. We know these trips can be arduous and patients often rely on the support of friends and family.”
The possibility of having access to less invasive or frequent treatments and of avoiding surgery altogether should have a positive impact on patients’ wellbeing and quality of life.
SUPPORTING OLDER PATIENTS
It’s difficult to predict the impact advances in treatments for older patients will have on the expected skills and knowledge of optometrists.
“Assessing functional vision – whether for driving or other activities – is a core part of their professional education and training,” says Michael. But, he suggests, variation in the availability of equipment in some practices, such as field screeners, can present a barrier.
Until the latest treatments are rolled out, optometrists can take measures to identify and support older patients with eye conditions. A number of best practices can be implemented to spot symptoms of diseases early and provide patients with help before their condition worsens (see Lifestyle advice on opposite page).
Optometrists can also play a role in optimising the quality of life of their older
patients. They can be given advice about their condition and directed to charities such as the RNIB and the Macular Society. Referral to the local low vision service can help a patient access visual aids, which can make a huge difference to a patient’s ability to continue with day-to-day activities.
“If a patient hasn’t been registered with sight impairment but meets the criteria, referral by the optometrist for ophthalmologist assessment and registration would be worthwhile, even if treatment for the condition is not going to be helpful,” says Tracey. “For a patient attending hospital eye clinics, an appointment with the eye clinic liaison officer [ECLO or eye care liaison officer] can be worthwhile, with the ECLO acting as a bridge between health and social care.”
Next time in Acuity
The next article in this series will explore the current strains on the optometry workforce and how these are set to be exacerbated by a growing older population.
find it too challenging to use computers and smartphones.”
It seems that early intervention is key – which is why optometrists play a crucial role in identifying older people in need of further support. Of course, staying aware of the latest developments in age-related eye disease treatment means optometrists are better equipped to inform patients. The most important skills they can develop, however, may relate more to emotional intelligence than technical abilities. Optometrists should take time to get to know their patients and ask about the difficulties they may experience in their daily lives. Establishing a relationship based on trust is key: some patients may otherwise be unwilling to disclose that they have problems.
In this context, patients are often able to receive information about benefits they’re entitled to, relevant charities and mental health support. Hospitals can also arrange a low vision appointment, where patients’ visual needs are assessed, and magnifiers can be loaned if appropriate – although interventions at this stage are often too late.
“The problem is that low vision services can be patchy across the UK, and many people are referred only when all medical intervention is exhausted or when they are certified as visually impaired,” Cathy says. “Referral at this stage, when sight is very poor, makes it harder for the person to manage the techniques of using, for example, magnifiers. Many high-tech pieces of equipment are too expensive for most people, and many older people
Addressing the issue of eye disease in an older population will be central to optometrists’ work for years to come. And the profession is well placed to contribute to finding solutions and improving outcomes for older patients – not least by continuing to educate the public about the importance of regular eye examinations at all ages, but also by advising their patients on changes they can make to their lifestyle to reduce the risk of eye disease, such as a good diet and smoking cessation.
COLLEGE RESOURCES
Visual impairment and road safety among older road users, a report of research by the College, funded through a Department for Transport Road Safety for Older Road Users Research funding stream: coptom.uk/3VSYiQO Vision and falls: coptom.uk/3iHLbED
Acuity WINTER 2023 31
Establishing a patient relationship based on trust is key
AGEING
CMO and ERM
Postoperative cataract surgery complications: cystoid macular oedema and epiretinal membrane
HISTORY
In July 2021, a 70-year-old female patient attended a routine eye examination, reporting a gradual decrease in vision both for distance and near in both eyes. She was a driver and a non-smoker and otherwise asymptomatic.
● General health: high blood pressure (well controlled), osteoporosis, breast cancer. No known allergies.
● Ocular history: no previous hospital eye service (HES) visits.
● Meds: statin (name unknown), amlodipine, letrozole and risedronic acid.
● Family history: nil relevant issues.
● Refraction and best corrected visual acuity (VA):
● Right eye (RE) +3.00/-0.50×90, 6/12, Add +2.75, N4.5 at 30cm.
● Left eye (LE) +2.75/-1.00×50, 6/12,
Add +2.75, N.6 at 30cm.
● Pinhole testing showed no improvement in VA in either eye.
Discussed with the patient the presence of epiretinal membrane (ERM) in the LE and potential risk for cataract surgery. These risks included reduced VA due to the ERM and risk of infection after surgery. Patient consented to be referred for cataract surgery in July 2021 and surgery took place on 16 December 2021 for the RE and 6 January 2022 for the LE, with no follow-up visits in between.
In February 2022, patient returned for shared care postoperative cataract appointment. Patient had noticed a general improvement in the vision in both eyes but not as great a result as the patient had hoped (LE>RE).
ANTERIOR EYE – USING CCLRU SCALE (BHVI SCALE)
RE Structure assessed LE
Clean/clear Lids/lashes Clean/clear
G1 redness
Conjunctiva
G1 redness
Clear Cornea Clear
Van Herick grade 3, quietAnterior chamber
POSTERIOR
Van Herick grade 3, quiet
● Unaided VA: RE 6/15, LE 6/120.
● Refraction and best corrected VA: RE +1.50/-1.00×110, 6/6-2, Add +2.50, N.5 at 30cm
LE +2.00/-1.50×80, 6/20, Add +2.50, N.10 at 30cm
● Pinhole acuity showed no improvement in either eye.
MANAGEMENT
The patient was urgently referred to HES for therapeutic treatment for cystoid macular oedema (CMO) and possible ERM peel surgery.
Patient was prescribed ketorolac 0.1% topically, three times a day for six weeks. Ophthalmology reviewed the patient again after six weeks (in April 2022), discontinued ketorolac and gave the option of an ERM peel for the LE. The patient was unsure whether to go ahead with secondary surgery and so returned to my practice for a follow-up refraction for new spectacles and an opinion on whether to go ahead with surgery.
Moderate cortical cataract Lens
Moderate cortical cataract 0.2 C:D (cup to disc ratio) 0.2
Clear – see OCT scan 1:1Macula
Mild ERM – see OCT scan 1:2
Clear Periphery Clear 18mmHg
Average intraocular pressure (IOP) using non-contact tonometry (NCT) at 11.20am
20mmHg
In May 2022, patient returned for re-refraction visit. Patient had noticed a significant difference in vision in the RE since using ketorolac. LE vision had also improved; however, it was still not as good as RE and had notable distortion.
● Unaided VA: RE 6/9, LE 6/15, Binocular 6/9.
● Refraction: RE +1.25/-1.00×115, 6/5, Add +2.50, N4.5 at 30cm.
Kathryn Marshall MCOptom, an optometrist working in community practice in Scotland, describes the surgical complications that can lead to reduced visual outcomes.
EYE – DILATED FUNDUS EXAM WITH TROPICAMIDE 0.5% AND VOLK 90D
TABLE 1 – JULY 2021 32 Acuity WINTER 2023 CASE STUDY
TABLE 2 – FEBRUARY 2022 33 CASE STUDY
OCT scan 1:1 RE no abnormality detected – poor scan image quality due to cataract.

LE +1.25/-1.50×80, 6/9, Add +2.50, N8 at 30cm.
● Pinhole acuity – no improvement for the LE.
OCT scan 1:2 LE mild ERM.
Overall, the patient was happy with the treatment result after the ketorolac and, after discussion, decided not to go ahead with the epiretinal membrane surgery. I did not refer back to HES as a review appointment was already arranged.
DISCUSSION
ANTERIOR EYE – USING CCLRU SCALE (BHVI SCALE)
RE Structure assessedLE Clean/clear Lids/lashes Clean/clear G1 redness Conjunctiva G1 redness Clear Cornea Clear Van Herick grade 4, quietAnterior ChamberVan Herick grade 4, quiet
POSTERIOR EYE – DILATED FUNDUS EXAM WITH TROPICAMIDE 0.5% AND VOLK 90D
CMO occurs when fluid causes cystic spaces to appear within the retina, specifically between the inner nuclear layer and the outer plexiform layer, which then thickens the retina and causes impairment of vision (Yamamoto et al, 2010). It is a complication that occurs after cataract surgery with an incidence of between 1.2% and 3.4% in uncomplicated surgical procedures. CMO is generally caused by an inflammatory response post-surgery and normally appears within four to six weeks post-op (Erikitola et al, 2021). CMO can be chronic (lasting from 72 to 249 days); however, most cases are self-limiting. Pre-existing ERM is a well-established risk factor for increased risk of CMO postcataract surgery (Henderson et al, 2007).

OCT scan 2:1 RE post-surgery – moderate CMO with no clear foveal pit.

OCT scan 2:2 LE post-surgery –severe CMO and ERM.
ERM presents on top of the retina and is not often accompanied by additional secondary pathology. It presents mainly in the over-50 age group, and there is a slightly higher proportion of females who present with the condition. The incidence of ERM varies widely in the literature (anywhere between 1% to 29%) and depends on ethnicity and age (Yang et al, 2018). ERM can remain stable, regress or progress depending on risk factors such as cataract surgery or vitreomacular traction. Data from the Blue Mountains Eye Study suggests that ERM may remain stable in around 39% of individuals, progress in 29% and regress in 26% (Fraser-Bell et al, 2003).
Clinical features
ERMs can be identified from fundus photography as a shiny, translucent layer on

Clear intraocular lens (IOL)Lens Clear IOL 0.2 C:D 0.2 Moderate CMO – see OCT scan 2:1 Macula Severe CMO and ERM – see OCT scan 2:2 Clear Periphery Clear 13mmHg Average IOP using NCT at 10.40am 17mmHg Moderate distortionAmsler grid Gross distortion (LE>>RE) Acuity WINTER 2023
top of the retina. Diagnosis can be refined via optical coherence tomography (OCT), where it is visible as a thickened and jagged layer above the inner limiting membrane (Goldman et al, 2018). The main patient symptoms with an ERM (depending on severity) are reduced vision and metamorphopsia. With mild ERMs, the patient is often asymptomatic; however, a good way of spotting changes in visual function is through regular self-monitoring with an Amsler grid chart (Folk et al, 2016).


CMO is very similar to ERM in terms of patient symptoms. However, the main difference is usually a greater drop in vision in the former, which may be corrected by a hyperopic shift in the refraction due to the macula thickening, which displaces the fovea more anteriorly.
Di erential diagnosis
● Wet age-related macular degeneration (AMD) – this was unlikely in this case due to both eyes being affected, and the vision would not typically improve as well as the RE did after refraction. Rather than cystic spaces, subretinal fluid would be present and possibly a choroidal neovascular lesion in wet AMD. Typically, this would produce marked reduced vision in one eye and metamorphopsia (Spaide et al, 2020).
● Central serous retinopathy – possible but unlikely in this case as the mean age of this patient group is typically 20 to 50 years old and the typical patient is usually male. The fluid pattern on OCT would also show fluid causing a detachment of sensory retina rather than cystic spaces within the sensory retina (Kitzmann et al, 2008).
● Full thickness macular hole – unlikely in this case due to both eyes being affected.
3 – MAY 2022
POSTERIOR EYE EXAM USING VOLK 90D LENS
REStructure assessed LE
Clear IOLLensClear IOL 0.2 C:D 0.2
ClearCorneaClear
Clear –see OCT scan 3:1
MaculaMild CMO and ERM, much improved – see OCT scan 3:2
ClearPeripheryClear 10mmHgIOP using NCT at 12 noon
14mmHg
No distortion Amsler gridGross distortion (LE>>RE)
This causes a profound loss of vision typically in one eye due to full loss of retinal tissue including the photoreceptor layer and metamorphopsia (Goldman et al, 2018).
● Lamellar hole – can also cause loss of vision and metamorphopsia. This is caused by a loss of some (but not all) of the foveal tissue which shows up clearly on OCT and the photoreceptive layer is still intact with cystic lesions often absent (Goldman et al, 2018).
● Vitreomacular traction – again unlikely in this case due to both eyes being affected however not impossible due to the history of bilateral surgery. When using OCT there would be a clear adhesion of the posterior hyaloid to the macula and a traction pulling upwards which would then cause vision to be reduced with symptoms of metamorphopsia (Goldman et al, 2018).
Treatment
Effective CMO treatments include both topical corticosteroids and non-steroidal
anti-inflammatory drugs (NSAIDs), but there is a lack of consensus on the specific approach. Ketorolac is an NSAID indicated for reducing inflammation after ocular surgery, with several robust clinical trials showing safe and effective application in treating CMO. Other treatments for retinal inflammation include intravitreal anti-VEGF [vascular endothileal growth factor] injections and corticosteroid implants, but the evidence supporting their use in treating CMO is limited (Han et al, 2019).
ERM can be treated using pars plana vitrectomy and an internal limiting membrane peel. The success of the surgery depends on several factors, including age of the patient and ganglion cell complex layer thickness. The lower the initial VA, the more likely there is to be a worse outcome after surgery. The higher the amount of initial distortion, the more likely it is for the distortion to become worse after surgery. Typical criteria for surgery would include the level of acuity, the impact on day-to-day quality of life of the patient and whether there is any detrimental effect on their binocular vision (Luliano et al, 2019).
LEARNING POINTS
● Manage patient expectations in terms of surgical outcome and always discuss risks of surgery.
● Have a good understanding of treatment of complications after cataract surgery, such as CMO and ERM, to advise the patient what their management plan may involve.
● Maintain a good relationship with local ophthalmologists to get advice on cases such as this.
OCT scan 3:1 RE post-ketorolac treatment – no notable inflammation and distinguishable foveal pit. OCT scan 3:2 LE post-ketorolac treatment – persistent CMO and mild ERM.
34 Acuity WINTER 2023 CASE
TABLE
STUDY
WAXING AND WANING
The visual cortex is at the back of the head, within the occipital lobe and, as Tony Morland, Professor of Psychology at the University of York, explains, it is the “first part of the brain that receives input from the eyes”. Distributed across both hemispheres, it constitutes a map of the information received by our eyes, with input from the right half of our visual world mapped onto the part of the cortex in the left hemisphere, and vice versa.
We know that conditions such as stroke, traumatic brain injury, brain tumours and dementia can all affect the visual cortex and lead to vision problems or even visual impairment and blindness. A stroke affecting the left hemisphere, for example, may cause vision loss in the right eye, even though the eye itself is unaffected. Similarly, traumatic brain injury can cause field loss, binocular dysfunction and spatial perceptual deficits (Frankowski et al, 2021). A tumour in the occipital lobe can cause loss of vision, visual disturbance and hallucinations. Posterior cortical atrophy (PCA), a rare form of dementia,
appears to be caused by damage to the visual cortex. For several years, researchers have investigated the question of whether sight loss resulting from eye disease would be reflected in the visual cortex. If so, when does the deterioration begin – and what are the implications for the treatment of patients?
Answering this question is not straightforward. Whereas the effects of a stroke or a brain injury on the brain are immediately detectable on an MRI scan, the brain of a person with, for example, age-related macular degeneration (AMD) looks perfectly normal. Tony says that, to

IMAGES: GETTY
As age-related macular degeneration progresses, part of the visual cortex starts to atrophy. But which way does the causal relationship work, asks Kim Thomas, and what does it mean for treatments focused on the retina if the brain has entered an irreversible decline?
35 Acuity WINTER 2023 AMD
observe changes, it is necessary to take MRI scans and then carry out “a lot of quantitative measurements for each individual and then compare the groups”.
The first evidence that there could be a relationship between loss of vision and deterioration of the visual cortex came with the publication of a 2005 paper, of which Tony was a co-author (Von dem Hagen et al, 2005). This found that some individuals with albinism, who have reduced visual acuity as a result of structural features of the retina, also experience atrophy in the visual cortex.
A ‘LINCHPIN FINDING’
The next major piece of research, from 2009, found a relationship between certain conditions, such as glaucoma and AMD, and atrophy of the visual cortex (Boucard et al, 2009). Significantly, the atrophy in the visual cortex closely matched the locations of damage within the retina. In patients with AMD, the part of the cortex representing the macula shows atrophy, whereas in patients with glaucoma, where the visual loss is more peripheral, the atrophy is in the part of the visual cortex representing the peripheral region. This, says Tony, is a “linchpin finding” that has formed the basis for subsequent research. The paper’s authors suggested that the degeneration of the visual cortex over time might lessen the effectiveness of proposed therapeutic strategies such as artificial retinal implants.
Another step forward came in 2014, when researchers looked at patients with AMD and juvenile macular degeneration (JMD) and found that, while in those with JMD atrophic changes were largely limited to the visual pathway, in patients with AMD there was also white matter atrophy in the frontal lobes (Hernowo et al, 2014). They concluded that this white matter atrophy might be related to a previously reported association between AMD and mild cognitive impairment.
Subsequent research has added to our knowledge of the relationship between eye conditions and visual cortex atrophy. A
2016 paper reported that, in patients with glaucoma, reduced visual cortex activity occurred before patients showed impairment in the visual field (Murphy et al, 2016). In 2019, Rachel Hanson and her colleagues investigated the pace of deterioration of the visual cortex in seven patients with a diagnosis of wet AMD (Hanson et al, 2019). MRI scanning was used to examine the visual cortex at three points: a baseline assessment shortly after diagnosis, before patients received anti-VEGF (vascular endothelial growth factor) treatment; three to four months after the baseline assessment; and five years after the baseline assessment. At the short-term assessment, the visual cortex did not show signs of atrophy compared to the baseline. At a five-year assessment, however, the patients did show signs of atrophy, which was largely limited to the representation of the central visual field.
ATROPHY AND NATURAL AGEING

The fact that the atrophy is not present in the months immediately following diagnosis is encouraging for those developing treatments for AMD. As Dr Heidi Baseler, Senior Lecturer in the Hull York Medical School at the University of York, and a co-author of the Hanson paper, says: “If there are treatments that might restore vision in the eye – for example, special drugs, surgery or stem cells – then we need to make sure that we do that early enough, before the brain starts to atrophy.”
Is there a possibility that the atrophy might be explained by natural ageing? Tony, who also co-authored the Hanson paper, says that age-related changes in the brain “usually occur in regions outside the visual cortex more rapidly than they do inside the visual cortex. The visual cortex is quite robust to age-related changes.”
This has been confirmed by Dr Holly Brown, Lecturer in Cognitive and Neuropsychology at the University of Huddersfield, whose PhD researched a group of patients with advanced bilateral
AMD as well as a control group. The patients’ brains were scanned multiple times over a two-year period. “We also incorporated some different MRI measures so we could look at different structures and get more sensitive measures of the changes, so we didn’t just look at the grey matter in the visual cortex, but also the integrity of the white matter projecting into it,” Holly says.
The research suggests that, in patients with AMD, the deterioration in the visual cortex may be faster than in sighted controls. Holly also found that atrophic changes in the cortex may also occur in white matter – in other words, outside the heavily myelinated layers that represent the input from the eyes. No changes emerged over the two-year period of the study, but AMD patients did show an overall reduction of structural integrity in the white matter compared with the sighted group, suggesting changes happened earlier. This opens up a promising avenue for future research.
We don’t yet know whether structural changes differ between patients with unilateral sight loss and those with bilateral sight loss, as studies have so far looked only at those in the latter group. The challenge to researching patients with vision loss in only one eye, says Heidi, is that, by the time patients realise there is a problem with their vision, the second eye is already affected: “It’s rare that you would get complete involvement in only one eye but not the other.”
36 Acuity WINTER 2023 AMD
AMD AND DEMENTIA
Past research has also found a significant association between AMD and dementia (Rong et al, 2019). Heidi has supervised a student, Leah Kelly, who looked at the links between AMD and the loss of cognitive function in dementia. Her study of patients with AMD found atrophy in the entorhinal cortex, which is also a feature of Alzheimer’s disease.
We know that there is some atrophy in the entorhinal cortex as a natural effect of ageing, but research suggests that physical activity may slow down the decline (Bugg and Head, 2011). In their AMD research, Leah and Heidi found a correlation between physical activity levels and cognitive scores, suggesting a causal relationship: perhaps people with sight loss have less opportunity to exercise or may be less active, leading to atrophy. This raises an opportunity for more research, Heidi suggests, in how to protect individuals from additional decline once they’ve lost their vision, and how a lack of input from the eyes might affect other brain areas, and other types of function besides vision.
Anti-VEGF drugs, injected into the eye, bind and inhibit the VEGF that is causing the leakage from the blood vessels. But Tony suggests that atrophy of the visual cortex over time does not have an impact on the efficacy of the medication. “A lot of the patients we have studied have been on anti-VEGF treatments, and as a
Measuring cortical thickness
T1-weighted MRI image showing the boundary between the white and grey matter surface, referred to as the white surface (yellow line), and the grey matter and cerebrospinal fluid, referred to as the pial surface (red line). The distance between the white and pial surfaces gives the thickness at each location of cortex (white line).

consequence we have been able to monitor their visual function,” says Tony. “We’ve shown, as other groups have shown, that their visual performance is largely maintained as a result of the anti-VEGF treatments. Wet AMD is largely arrested by those treatments.”
Treatment options for AMD will continue to focus on the retina – either preserving or restoring its function. The challenge is that, once the visual cortex has started to atrophy, it may be impossible to reverse. So even if treatment successfully restores the function of the retina, the atrophy of the visual cortex, where the retinal signals are processed, may limit the visual outcome of such treatments.
Tony points out, however, that historical research has shown that, in people with some vision loss, stimulation of the visual cortex with a magnetic field can induce a visual experience – although the longer the person has had vision loss, the more stimulation is needed to produce the experience.
This provides evidence that the longer the visual cortex is left without an input from the eyes, the less responsive it becomes.
Although research has made promising advances in our understanding of AMD’s effects on the visual cortex, there is still much to explore.
The next stage of research is to use more advanced imaging techniques to examine the changes in the visual cortex in greater detail. Tony hopes he might be able to gain access to brain banks, enabling him to carry out a microscopic evaluation of the brain tissue of donors with AMD to see if it can provide further clues to the nature of change in the brain.
At the moment, it’s possible to see tissue shrinkage, but researchers would like to identify the reason for the shrinkage and therefore whether it’s reversible.
“The idea of looking at microscopic changes is to see whether specific cell types might be targeted, or if maybe the cells are absolutely fine, and once you restore vision in the eye they just pop right back to life,” says Heidi.

37 AMD Acuity WINTER 2023
IMAGE: HANSON ET AL, 2019
whether genetic nurture plays a significant role in childhood development of myopia alongside a person’s built-in genetics.
myopia a person’s built-in g










etic nurture lopment of ti









ene cs.

38 GENETICS IMAGES: XXXXXX
IMAG MAG G AG MA M ES: E : S ES XXXX XXX XX X X XX X XX X X
Acuity W I N TER 2 0 2 3
Adrian O’Dowd investigates
CPD AVAILABLE ONLINE
esearch has claimed that refractive development is influenced by both environmental and genetic factors, and there is evidence that environmental influences and individual






play vital roles in the susceptibility of people in developing myopia (Wojciechowski, 2010).

amount of the variance of refractive error within a population is due to direct inheritance.



UNEXPECTED RESULTS
A recent study (Guggenheim et al, 2022) found that genetic nurture appeared to have no significant impact on the development of


behavioural factors influential environment have also said that a significant impact on the of refractive errors – a finding that the
Experts have also considered the impact of genetic nurture – the genetic effects transmitted indirectly from parents to a child, or from “virtual parents”, such as through an influential environment. However, they have also said that a signifi
39 GENETICS
Acuity W I N TER 202 3
authors themselves found surprising. They started out by expecting that there could be a place for genetic nurture in myopia development and carried out an analysis in 1,944 pairs of adult siblings from the UK to quantify the proportion of the genetic risk of refractive error contributed by genetic nurture.
The study’s main author, Professor Jez Guggenheim MCOptom, from the School of Optometry and Vision Sciences at Cardiff University, explains: “There has been a long-standing paradox in the myopia research field about the interplay between genetics and lifestyle.
“Twin and family studies have suggested that refractive error is largely determined by genetics. Yet clinical trials of myopia control interventions and epidemiology studies from diverse regions point to a major role for the visual environment.”
In addition, genetic nurture has been shown to explain some of a child’s predisposition to educational attainment. Gene-environment interaction is a plausible explanation for what is happening here.
GENE-ENVIRONMENT

INTERACTIONS
Genetics may govern a child’s predisposition to myopia but, in order to actually develop common myopia, the child also needs to be exposed to an environmental trigger, such as insufficient time outdoors or intensive education.
This model could explain why, in countries such as Singapore and Taiwan, which have ultra-intensive education systems, many children develop myopia – 65% of Singapore students have myopia by the age of 12 (Karuppiah et al, 2021), and 76% of 12-year-olds are myopic in Taiwan (Tsai, 2021).
“Given the link between education and myopia, the link between genetic nurture and education, and the paradox of a central role for both genetics and lifestyle in determining refractive errors, an important role for genetic nurture in myopia development seemed likely,” Jez says.
Nevertheless, in their new study, the authors found no evidence of a contribution from genetic nurture. As Jez says: “It was quite a surprise to find no evidence of a role for genetic nurture.
“We even carried out analyses of educational attainment, using the same sample [UK Biobank participants] and the same methods, to make sure we hadn’t made a mistake in our calculations.
“That said, our analysis had limited precision. This meant we could not completely rule out a role for genetic nurture in refractive error, but our results strongly suggested that direct transmission of genetic susceptibility from parents to children was the major route by which genes influence myopia development in our study population.”
Dr Neema Ghorbani MCOptom, Assistant Professor at the School of Optometry and
“There’s a lot more still to be discovered because this is just a single study, and further research will need to be done, but it doesn’t detract from the main idea that parents who are short-sighted usually have short-sighted children,” says Neema.
“General myopia in recent populations is likely more environmental than it is genetic. If you have a lifestyle that involves staying indoors and you are staring at a screen all the time, you are more likely to become short-sighted.
“If your parents raise you in that sort of environment, which could be because it also matches how they were with their lifestyle, then it makes sense.
“However, what we are finding from [the study] is that, although the parental risk remains, it appears to be less due to the influences of myopic parents on the children’s lifestyle. Indeed, it might be primarily through direct genetic inheritance, which may be unexpected.”
Professor Chris Hammond, Professor of Ophthalmology at King’s College London, came to a similar conclusion in a previous study, which analysed more than 2,000 pairs of twins to look at the role of shared environment in refractive error and examined what the genetic and environmental contributions were to myopia (Lopes et al, 2009).
WINTER 2023 40 GENETICS IMAGES: ISTOCK / SHUTTERSTOCK
Myopia in recent populations is likely more environmental than it is genetic Acuity
Vision Sciences at University of Bradford, says the study’s findings highlight the need for more investigation.
Chris says: “We showed in the twin study that there really didn’t seem to be much shared family environment in myopia. The recent Guggenheim study reinforces what we found.”
It may be that the concept of genetic nurture could shed some light on other ocular conditions among children or in their ocular development as a whole.
Cathy Williams, Consultant Paediatric Ophthalmologist at Bristol Eye Hospital and Professor of Paediatric Ophthalmology at Bristol Medical School, argues: “Ocular development largely occurs in utero. During this time the environment of the foetus is largely controlled by the mother and her lifestyle choices (which may be partly genetically determined) – so diet and exposure to cigarette smoke or alcohol can affect ocular development, particularly the optic nerve.
“As we learn more about the interplay between the environment, including lifestyles, and the development of disease, we may well find genetic nurture is an increasingly useful theory to help understand the eternal ‘nature versus nurture’ question.”
CLEAR ANSWERS
It is difficult to get a clear answer on the role of genetic nurture versus nature when it comes to the development of myopia, but the relentless progress of science – including the reduced cost of sequencing a person’s full genome – may offer hope.
Jez says: “Large-scale studies around the world are embarking on sequencing the genomes of thousands of individuals, which will make it possible to address – definitively – the genetic contribution to a disease or trait. It is already apparent that most commonly occurring diseases, such as cataract, glaucoma, age-related macular degeneration and myopia, result from a combination of genetic risk factors and lifestyle risk factors. Yet, in any specific patient, the role of genes or the role of the environment can be decisive.
“With funding from the Welsh Government and Fight for Sight, we’re
Definitions of genomic terms
ALLELE – different forms (matching) of the same gene, one from a person’s mother and one from their father. They can be identical but also have slight differences.
ASSORTATIVE MATING – a mating pattern and a form of sexual selection in which individuals with similar phenotypes or genotypes mate with one another more frequently than would be expected under a random mating pattern.
BEHAVIOURAL GENETICS – the science of how nature versus nurture influences a person.
COMPLEX TRAIT – a trait with a genetic component that does not follow strict patterns of how traits are usually passed from parents to their children. It might involve two or more genes interacting or gene-environment interactions.
GENOMIC MEDICINE – the study of genes and how they interact with a person’s health. Sometimes this is described as personalised or precision medicine.
GENOTYPE – the combination of two alleles that a person inherits.
PHENOTYPE – total observable characteristics of individual and physical properties, resulting from interaction of the genotype with the environment.
(JAMA, 2013)
evaluating how well we can predict children’s genetic susceptibility to high myopia. Eventually, we may be able to screen children for high myopia risk in the same way we currently use tonometry to screen for individuals at risk of glaucoma.”
FURTHER RESEARCH
Experts in the field have a consensus on one thing at least – more research is needed on the issue.
Chris argues: “We still know very little about the exact mechanism, and in particular how the environment influences our genetic risks to make us myopic. The holy grail is the gene by environment interactions. For instance, are there any particular genetic variants that mean that, if you are exposed to a factor – such as not enough light – you are very likely to become myopic? Or are there any particular genetic variants where you would respond well to one treatment to slow your myopia progression compared with another treatment?
“We are interested in the genetics of trying to find the mechanisms that are involved and which we might therefore influence. It would be useful to have the equivalent of a statin for cholesterol. With ‘personalised medicine’, we might try to find people with particular genetic combinations that either make us think
they’re likely to become myopic so we might prevent it, or we try to predict who would respond to which intervention now that there are many on the market, or we personalise treatment for them.
“There is a lot of work going on into improving how we measure the environment in a child in terms of how much light they are exposed to and how much close work they do and how intense their work is.”
Jez adds: “We are keen to find out if genetic nurture plays a role in myopia development in contemporary European populations. The UK Biobank participants we studied mostly went to school in the 1960s and 1970s. Things could be different for current generations of children. We would also like to study children living in education-intensive environments such as Singapore, Taiwan and Hong Kong.”
Neema agrees: “We need to do a similar study in other populations and we should try to use data from children as they’re growing up: it might be that the short-term effects from nurture could be captured at a critical time of change, rather than when they have reached adulthood.”
A longer version of this article is available online at bit.ly/3GcmiZz
Acuity WINTER 2023 41 GENETICS
top tips from Denise for engaging staff
1
Listen to your staff Make them the heart of the discussion.
2
Look at yourself as a leader. Think about your story, vision and the why, then see if you can communicate that back to your staff so they’re all on board.
3
Invest in coaching.
It’s about tapping into and nurturing the talent of people you’ve hired. If you see somebody who’s good at something, push it.
Denise Voon
MCOptom Prof Cert Med Ret
How did you get into optometry?
I worked as a Saturday girl in an optician’s and, around that time, my dad had significant eye problems. Being able to research them for him got me really interested in optometry.
You were previously principal optometrist at Buckinghamshire Healthcare NHS Trust for many years. What was your role there?
I started off as a junior member of staff in our core optometry clinics, including paediatric refraction, low vision and complex contact lenses (CLs). As I became more experienced, I took on additional roles in a general ophthalmology clinic, postoperative cataract, diabetic retinopathy screening and, later, in age-related macular degeneration (AMD).

The biggest change to my role was when I moved into management as deputy head of the optometry department there. That’s where I became passionate about coaching and mentoring.
The macular disease clinic at Amersham Hospital recently celebrated five years of award-winning service. What was your role in developing the clinic, and is that where your interest in service redesign and development started?
We were really fortunate to have forward-thinking consultants in our AMD service, constantly asking us what we could change or do better.
That really sparked my interest in service redesign and how we can apply it to optometry and other aspects of eye care. I was also fortunate to be able to do a QSIR [quality, service improvement and redesign]
course, which gave me the foundations for how to set up the AMD clinic.
We did a lot of work with patient trackers to identify bottlenecks in our clinic and make the service truly efficient. Generally, a patient at our AMD clinic will have their vision, scans and photos done, see a doctor or optometrist, have their injection and be out within an hour.
Also, I really wanted to show people with visual impairment that they don’t need to just sit there and listen to their audio books. There are lots of things they can do out there. We put on cooking demonstrations, visually impaired tennis sessions and art projects.
How does QSIR support your practice and ultimately help to achieve better
eye health outcomes?
Firstly, a lot of our service redesign is about capacity and demand: how can we see as many patients as possible safely and efficiently? When you look at AMD around the country, there are generally huge backlogs. If people don’t get their treatment on time, it could lead to avoidable sight loss.
Our consultants are also really invested in the staff ’s wellbeing. Ultimately, we’re the people that deliver the service and if we’re chronically
The College’s Clinical Adviser on her award-winning work at Amersham Hospital.
WHO? Denise Voon CURRENT JOB? Clinical Adviser WHERE? College of Optometrists
CAREER PROFILE Acuity WINTER 2023 42
overworked, it’s going to fall down, no matter how well designed it is. So they’ve developed a nice work environment where people want to work hard and also feed into how to make things better.
You recently took up the post of Clinical Adviser at the College. Why was this role an exciting prospect for you and what does it entail?

It’s so varied, which I hadn’t foreseen. At one end of the scale, we’re dealing with individual member queries and answering clinical concerns. At the other, it’s lobbying for the advancement of the profession and being the authoritative voice of the whole sector. The College is also working towards its new Workforce Vision – roles, services and pathways – which is using optometrists to help improve capacity issues in secondary care.
What do you hope to achieve in the role?
I’d really like to help the stakeholders and the wider eye care profession understand the importance of what we, optometrists, can do. We’re skilled enough to diagnose and treat many conditions and, where required, we can better support secondary care services. It’s about making our skills known and upskilling the profession to be able to meet the demands put on us. I’d love to see optometry play a bigger role in eye care.
What did winning the Macular Society’s Optometrist of the Year award for your work at the Amersham clinic in 2019 mean for your career?
It was really special and humbling. Being nominated by a patient made me realise the impact and influence I have as a clinician on people’s lives. I couldn’t have done it without the support of all my colleagues either – we achieved it together.
Fast facts: Sew talented

d t e
What would people be surprised to learn about you?
If I hadn’t become an optometrist, I would have been a professional golfer.
What do you like to do in your spare time?
Sewing, baking, walking and cycling.
What is your favourite sport? Horse riding.
What or who are you most proud of?
The people I’ve mentored.
If you were to describe yourself in three words, what would they be? Loyal, passionate, kind.
Do you have any advice on time management that has helped you deliver across clinical practice, management and research?
Be honest with your work/life balance. If you have a family and being there for them is important, don’t feel obliged to be in clinic all the time. Also, be kind to yourself and work on your wellbeing. Work without downtime can lead to the point where you can’t deliver anymore. Show yourself compassion and learn to say no.
What do you think have been the most exciting developments in optometry recently?



The eye care models of Wales and Scotland are moving towards the premise that optometrists are going to be the first port of call for ocular problems.
How would you like to see the profession grow in the short-term?
I’d really like to see optometrists upskilling themselves and getting the experience they need so that, when the opportunity arises, they’ll be ready to go. Higher qualifications from the College are brilliant; I’ve done one myself, and they’re a great way of improving your knowledge.
COLLEGE GUIDANCE

Find advice on planning your career at coptom.uk/3ByO0xf
The College’s Workforce Vision: coptom.uk/3hBNl8w
IMAGE: ISTOCK
Optometrists are skilled enough to diagnose and treat many conditions
43 CAREER PROFILE Acuity WINTER 2023
eforms of the NHS in England, Scotland and Wales mean there is an increasing need for optometrists to get involved. So how do you make a difference? Does it always have to be a major commitment, or are there easier ways to take part in shaping the profession? And what’s the r eward, personally and professionally? We asked current and future leaders.
Farra Raqib MCOptom is Chair of the local optical committee (LOC) in Derbyshire. “I got involved out of curiosity. What is going on with systems? Why are patients not being seen when I feel they need to be seen in hospital?

“I realised there was such a misunderstanding of what clinical care optometrists can provide. There are a lot of other professionals who think it is all about glasses, completely neglecting the whole healthcare side. I’ve sat with other clinicians and said, ‘we know how to do Goldmann applanation tonometry,’ and they have been shocked.”












Optometry Scotland has been integral in responding to the Scottish Government’s inquiry into primary care and reducing pressure on GPs. Chair Julie Mosgrove
MCOptom says it’s a real opportunity for optometrists to step forward. “There will be a lot of changes in the profession in the coming years. It’s about keeping up to date with them and helping shape the future.”
Kaye McIntosh advises on getting involved in systemic changes.
DRIVING CHANGE
What drove Julie, also Retail Director at Duncan & Todd optometrists in Aberdeen, to get stuck into the profession as well as the day job? “I’ve always been excited by driving change. I also like to learn from others, sharing best practice.”
There’s huge satisfaction in making things happen. Derbyshire LOC helped to set up a Minor Eye Conditions Service (MECS). Farra says: “There was a lack of understanding of

Speak up and shape the

44
Acuity WINTER 2023 HOW TO...
If you do come forward, how can you make the time?
R
what optometrists could do clinically across the system, and as such we faced resistance from secondary care initially. They were worried about the quality of care that would be delivered. Through nurturing the understanding of the competencies of optometrists and opticians, we achieved the roll-out of the MECS across Derbyshire.”
The MECS means many patients are sent to optometrists rather than having

to go to hospital, reducing pressures on both A&E and ophthalmology outpatients and improving the patient journey. Farra says: “The reward is great when you see a patient who comes in with something they think is scary and is actually reassured and managed in the practice, without sitting in A&E.” The scheme avoids patients being added to ophthalmology waiting lists and has been well received by patients. It has
Attending your first meeting

1 Before the meeting, ask whether the chair could remind everyone to explain jargon and acronyms.
2 It’s fine to just listen, observe and reflect.
3 If you want to speak, write down what you want to say so you don’t forget it.

4 See if you can go along with a colleague or more experienced member.
5 Remember, there’s no such thing as a silly question. If you’ve done your research and can’t find an answer, then there are probably lots of other people wondering about the same thing.



6 Be prepared for not all your contributions being accepted. But challenge is good and leads to better decision-making. Just listening to the process and having your voice heard is an important part of your reflection.
The rewards
There’s a lot to gain from representing the profession.
● On working in the consulting room, Farra RaqibMCOptom says: “It is rewarding but it can become a little monotonous. When you come out and you work on the systems you realise what a difference the optical sector makes to the NHS as a whole; it takes you from the micro to the macro sphere.”
● Ian Jones MCOptom says joining committees and groups can help you with stress: “There’s an element of sharing the experience of the day job; offloading is quite useful when the job’s been stressful. There can be some good gossip, swapping funny stories.”
● Contributing to the profession also helps your career, Rashida Makda MCOptom says. “It helps you study topics from different perspectives and makes you a better clinician, while keeping you up to date with all the latest changes.”
● Julie Mosgrove MCOptom says it also helps your personal development. “We learn a lot both clinically and professionally, and it’s a really good way of building up your network.”
 IMAGE:
IMAGE:
ISTOCK future 6
45 HOW TO... Acuity WINTER 2023
also led to a “much more robust relationship” with secondary care and commissioners, she adds, while undertaking this work can lead to concrete and effective changes.
But engagement at other levels is also important. It can be as simple as responding to surveys and consultations, Julie says. “Health and optometry bodies are always asking for your opinion. We need honest answers about how you feel things will work.” Contributing to surveys doesn’t require a regular commitment and can be less daunting for those looking to get more involved in the wider profession for the first time.
Member input to a survey and focus groups informed the College’s submission to the General Optical Council (GOC) on reform of the Opticians Act. Olivier Denève, Head of Policy and Public Affairs at the College, says: “We used our members’ feedback to inform our recommendations to the GOC as part of our evidence submission.
“It is always very important for us to listen to members’ concerns to better understand the challenges they face locally as it helps us shape our policy and influence activities.”
GETTING INVOLVED
There are opportunities for all kinds of involvement through your LOC. Ian Jones MCOptom, Partner at Davies and Jones Optometrists and Member of the South East Wales Regional Optometric Committee, says: “You’ll be very welcome just to come in and observe, so you get a feel for what’s going on and can feed it back to your own practice.”
Bodies such as your LOC or Optometry Scotland send out regular information that will alert you to roles on NHS organisations such as health boards.
LOCs also offer the chance to work with a variety of professionals from the wider NHS. Derbyshire LOC links to the Derbyshire Expert Advisory Forum, which supports the integrated care board (ICB), bringing together clinicians from
Get involved with Acuity
There are lots of ways to contribute to your membership journal.
● Submit a case study.
● Answer the “How would you?” topical question we ask every issue.
● Become a contributor. Offer to be interviewed on a topic of your choice.
● Tell us what you would like to read about. See coptom.uk/3veeXmZ
secondary care, orthoptists and ophthalmologists, commissioners and public health.
In Wales, a new NHS contract was announced in October. Ian says it’s a great opportunity to help shape the future of the profession. The Welsh Government is keen to speed up development of clusters, local groups that bring together primary care services, in a programme called accelerated cluster development. “The Government wants to change the cluster structure so it’s no longer GP-dominated,” Ian adds.
Every optometry practice in Ian’s cluster, Taff Ely in Cwm Taf Morgannwg University Health Board, has been offered £1,000 a year in a pilot scheme to engage in cluster work, including providing Welsh Eye Care Centres in domiciliary settings, with equipment grants for items such as handheld slit lamps.
The new system opens up fresh areas. Ian says: “The role of clusters may be more about public health. That’s opening new doors: we can look at weight gain, where clusters will be providing slimming club vouchers, or smoking cessation.”
MAKING TIME
If you do come forward, how can you make the time? Farra says it doesn’t have to be a huge commitment. “I have committee members who are there to give us their valuable opinion and those who are active in our forums, such as the expert advisory board that plugs into the ICB.”
Rashida Makda MCOptom is a newlyqualified optometrist working in Leicestershire. She was the College’s first Early Career Representative, sitting on Council and feeding in the views of
students and trainees, and she also sits on the Acuity editorial board.
“I try to pencil meeting dates in my diary in advance,” she says. “I don’t see it as extra work; it feels more like further learning as part of my role is to give comments about articles to be published.”
She adds: “It is important to get involved at an early stage in your career, to stay in touch with the most recent changes within our profession.”
Julie says it’s crucial her firm is on board. “My company really supported me by arranging my time commitment around Optometry Scotland. The Managing Director agrees that what happens there impacts the future of the business.”
Responses to the College on the Opticians Act reforms have prompted it to look at ways members can contribute to its growing policy and influence activities. Olivier says: “This work is at an early stage, but it is a key priority for the College.”
It will be just one of the many opportunities that are there to be grabbed to get involved in the wider profession at all sorts of levels – and that can make a difference to your career, as well as the wider profession.
MEMBER RESOURCES
Contact the College Policy team with your queries or ideas at policy@college-optometrists.org
Join a College of Optometrists reference group. See coptom.uk/3YEVI3H
For volunteer and paid opportunities at the College, visit coptom.uk/3WiWlhK
46 HOW TO... Acuity WINTER 2023
ccording to Health Education England, the fundamental principles of health coaching are intended to help patients self-manage their health condition in pursuit of their goals. This is a radical change from a historically paternalistic culture, where health professionals exercised control in how care is delivered, towards a shared decision-making process with the patient.
Based on behaviour change theory and forming part of the NHS Long-term plan, the technique is devised to equip people with the confidence, knowledge and skills to live healthier lives.
“Health coaching is the art of working collaboratively with patients to facilitate their active participation in managing their own health,” explains Dr Arti Maini, Deputy Director

GUIDE, DON’T TELL
How can health coaching improve patient outcomes and strengthen the patientpractitioner relationship? Sophie Goodchild explores the benefits and challenges of personalising care and empowering your patients.
IMAGE: GETTY
47 HEALTH COACHING Acuity WINTER 2023
A
of Undergraduate Primary Care at Imperial College London. “Health coaching approaches adopt a person-centred mindset and skill-set, and are based on trust and respect in the clinicianpatient relationship.”
Apart from treatment, the solution to unhealthy lifestyles that lead to poor health and poor eye health may appear obvious. That is for clinicians to tell patients to ditch unhealthy behaviours instantly: to quit smoking and drinking, eat a well-balanced diet and shed the pounds. However, patients do not always follow recommendations from optometrists, especially those delivered autocratically.
In contrast, the starting point in health coaching, says Arti, is the assumption that people are resourceful and are experts in their own unique life situation. Through health coaching, the healthcare practitioner’s role broadens. It moves from expert to enabler of a person’s “best thinking” about their health issue.
While the practitioner has important information to impart, the patient must have an active role in their care and achieving their health aims. Achieving these self-identified goals is at the heart of health coaching.
Health coaching can be applied in time-limited healthcare consultations with a wide spectrum of patients and health-related situations. The technique, says Arti, enables optometrists to have more flexibility during routine consultations.
“At times, the consultation may involve skills of diagnosing or informationgiving,” she adds. “Health coaching approaches enable you to further empower patients to identify their health aims and solutions.”
HOW COACHING CAN HELP WITH LIFESTYLE MANAGEMENT
In health coaching, the clinician and patient form an equal partnership. Many models and theories have sprung up in this field of behavioural change: motivational interviewing, which avoids challenge in favour of going at the

patient’s own pace; adult learning theory, which is based on the belief that adults learn differently from children; and the theory of change model, which maps how an intervention leads to a desired result.
The approach of Andrew McDowell, psychologist, health coach and Partner at TPC Health, is based on guiding, not telling – a fundamental principle of health coaching. He uses the behaviour change model COM-B (see panel). Capability, opportunity and motivation are all needed to successfully modify or gradually change a lifestyle behaviour, such as spending hours in front of a computer screen.
Questions a practitioner who adopts this technique might ask could include: “What capabilities do you need to follow through on taking screen breaks?” and “When, how and who else needs to know about this to support your opportunities for spending time away from your screen?”
Andrew suggests starting a discussion with a patient whose lifestyle may be affecting their eye health and who needs more support to manage their condition or adhere to a medication regime.
An example of how this discussion may start is as follows: “We’re here to talk about your glaucoma. What would you like to get out of the conversation?”
The COM-B model
This behaviour change approach is based on the principle that Capability, Opportunity and Motivation are capable of changing Behaviour:
CAPABILITY: Physical and psychological. The skills required to make the change and the knowledge to take steps towards it.
OPPORTUNITY: Physical and social. This includes time and cost considerations, and the presence of support.
MOTIVATION: Reflective and automatic. Patients gain motivation by considering the long-term benefits of the behaviour change. They use this reflection to see the behaviour change as a “want”, not just a “need”.
Andrew says most practitioners are good at following the rules by looking at data and patient history, but are not as skilled in empowering patients. “Altering our approach and adapting it for each situation requires effort and learning how to have a more personalised conversation. But if this doesn’t happen, people are unlikely to follow through with change.”
Other useful questions to ask patients, as suggested by Arti Maini, include: “What difference would it make for you if this condition was addressed?” (motivation) and “What do you already know about this condition and the steps you can take to improve it?” (capability, opportunity).
But do these methods work? Most health coaching studies are based on small sample sizes and short follow-up times, but have yielded some positive findings. Results from qualitative research into health coaching to develop eye drop adherence strategies among four glaucoma patients (Rosdahl et al, 2015) showed benefits in addition to adherence such as weight loss and improved work/life balance.
BENEFITS FOR LOW VISION PATIENTS
For low vision optometrists, health coaching is particularly relevant. Their
Acuity WINTER 2023 48 HEALTH COACHING
relationship with patients may already feel more collaborative because of the need to gain insight into the complex challenges their patients face.
Although not a trained health coach, Stephanie Cairns MCOptom uses healthcoaching techniques in a low vision clinic to perform assessments. Her patients will be at different stages or psychological states in their cycle of acceptance. Listening to and understanding the patient and their personal circumstances – not just their disease – and following up are all vital, says Stephanie. She explains that motivation to adapt their lifestyles depends on many factors, including any support that is in place and their self-confidence.
“The assessment should be the beginning of changing behaviour, a gateway to a wider network of support that involves the whole community,” she says. “Some patients are socially isolated so they may not know what they can access or how suitable any support or activity groups will be. For those already worried about falling due to sight loss, they are less likely to undertake exercise classes unless they’re given details of classes aimed at others like them. People need signposting to a variety of options to decide what’s right for them.”
A working partnership with patients is important for making a shared decision, to support people to self-manage and become part of the problem-solving process.
Besides, patients have a legal right to be involved in making choices about their medical treatment as outlined in guidance from the Patients Association (2022), a charity.
Its guidance adds that taking account of their needs and preferences is essential and can result in benefits such as patients having fewer regrets, decisions being made more effectively and improved patient health outcomes.
Practitioners can start the process of shared decision-making by taking assessment of a patient’s views, beliefs and values, and using health coaching to help to strengthen this two-way relationship.
HEALTH COACHING IN PRACTICE
How does health coaching work in everyday practice? An example given by Andrew is dry eye disease. Optometrists commonly recommend patients cut screen time. But Andrew points out that they’re unable to do this without the right tools such as eye drops, the opportunity to take screen breaks or the belief in their capability to change.
His approach would be to discuss the patient’s work situation with them, such as how long they spend staring at a laptop, phone or computer screen. This could help identify opportunities for taking breaks and to combine them with an enjoyable, healthy activity such as gardening. Knowing there is an additional health benefit can motivate a patient to make this change, he says.
Peter Greedy MCOptom, an optometrist and personal development coach, says the core techniques he uses include asking open questions and understanding a patient’s personal story, from the medication they take to their hobbies.
NO QUICK FIXES
Health coaching is not a quick fix – the process can take time to reap results.
Typically, a decision to change is not based on the first contact with a patient. Instead, it is about repeated messaging over time to help bring about change.
Stephanie says she’s had low vision patients who return for an eye test wearing
their old glasses because “they’re keeping the new pair for best”, those whose magnifiers lie unused in their boxes after two years and others who struggle to remember to put in eye drops.
“It may take a number of years for patients to come to terms with sight loss and adapt. If they’re told nothing medically can be done to help their sight, they can feel overwhelmed by the situation and unable to process that support is available, once accessed.”
Peter says suggesting immediate and major change is “often a disaster” because it’s too daunting. Instead, he suggests small changes that are manageable, and then revisits these at the next visit.
TAPPING INTO RESOURCEFULNESS
“People are resourceful, with inner strengths and capabilities,” Arti says. “They are much more likely to believe in their own resourcefulness if they sense that you believe this too.”
Reinforcing positive language or behaviours the patient is already displaying about their issue can be a powerful motivator for behaviour change. Examples include: “It’s great that you have already prioritised this issue by coming to see me today to discuss it” or “The steps you have already taken are an important start.”
Her key tips for good coaching include leaving the patient with increased awareness about their issue, autonomy to decide what to do about it and responsibility to take action.
For optometrists interested in implementing a health coaching approach in practice, the message is that the patient is the expert of their own life context.
Optometrists should always remember, she says, that patients are best placed to identify the solutions and make the decisions that will work best for them when it comes to their own health.
This is why, to optimise their patients’ self-knowledge, practitioners need to ask, not tell.
Acuity WINTER 2023 49 HEALTH COACHING
People are resourceful, with inner strengths and capabilities
Did
NHS sight tests were carried out in England in 2019-20. (NHS Digital, 2020)
(Getting It Right First Time, 2022)
SURVEY
took part in the survey are referred to as ‘respondents’. For more information about the methodology, see bit.ly/3BUgh2a
you know..?
IMAGES: SHUTTERSTOCK 13.4 million
29,300 GOC-registered
OVERALL JOB SATISFACTION HAS INCREASED BY SINCE
62% feel
17%
21%
WAS THE HIGHEST AMONG: People with a disability 32% Locums 27% People who work for a multiple 24% Optometrists 23% AMONG RESPONDENTS WHO WERE SATISFIED IN THEIR JOBS, THE MAIN REASON WAS: Education or academia 73% A hospital 71% Full-time employment 66% Domiciliary care 74% SATISFACTION WAS HIGHEST AMONG THOSE WORKING IN: 4 35% Enjoyable/ rewarding work
50 Acuity WINTER 2023 NATIONAL SNAPSHOT
600,000 patients are waiting for their first ophthalmic outpatient appointment. It will take over five years to clear the backlog.
THE OPTICAL LANDSCAPE IN NUMBERS
optometrists, dispensing opticians, student optometrists and student dispensing opticians in the UK. (GOC, 2022)
2021
satisfied
feel neithersatisfied nor dissatisfied
feel dissatisfied DISSATISFACTION
(GOC, 2022)
GOC REGISTRANT WORKFORCE AND PERCEPTIONS
2022 All GOC registrants were invited to take part in the survey. In total, 4,102 responses were received, a 14% response rate. As the survey was completed by a sample of GOC registrants, and not the entire population of registered optical professionals, the sample has been weighted by registration type: optometrist, dispensing optician, student optometrist and student dispensing optician. Throughout the report, those who

college-optometrists.org/jobs
about your next career move? Your ideal role could be on the College jobs board! Need
fill
members can
optometrists,
Thinking
to
a vacancy? College
advertise their current vacancies free of charge to thousands of
researchers and pre-registration trainees.

















































Scan the QR code to discover more about ACUVUE® OASYS MAX 1-Day! * Versus ACUVUE® OASYS 1-Day. Important Information for Contact Lens Wearers: MAX MAX *1 Also available in Multifocal ACUVUE® OASYS MAX 1-DAY CONTACT LENSES TEARSTABLE™ TECHNOLOGY OPTIBLUE™ LIGHT FILTER§ more of our eyes


























































































































 Evelyn Mensah Consultant
Evelyn Mensah Consultant

IMAGE:
IMAGE:



















































